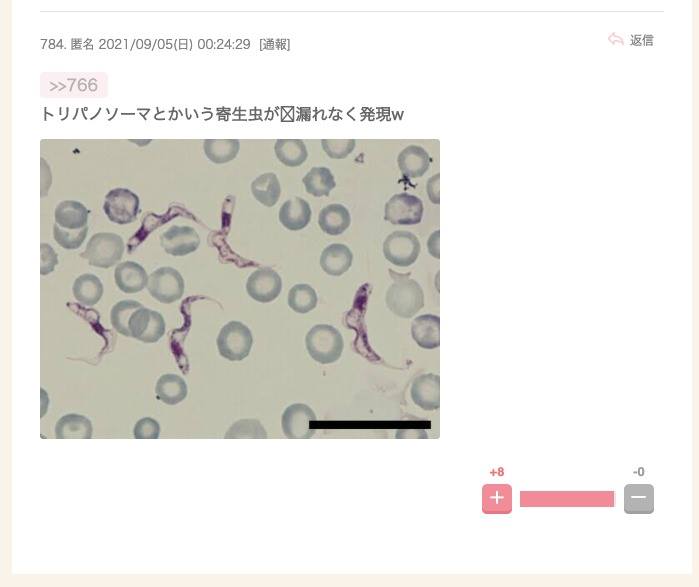

-
2001. 匿名 2021/09/09(木) 21:59:49
>>1959
あなたのことも見たことないし+1
-0
-
2002. 匿名 2021/09/09(木) 21:59:52
>>1995
私は上様か、医師会の会長がいいと思う+1
-6
-
2003. 匿名 2021/09/09(木) 21:59:52
>>1951
先生それ好きねー+1
-5
-
2004. 匿名 2021/09/09(木) 21:59:53
>>1255
気付くよね?みんなこんなこと分かるよね…。
でも洗脳されちゃうと何言っても無駄なんだよね。
で少数派がどんどん多数派に流れていってしまう。
やだな。もうどうしようもないのかな。+28
-4
-
2005. 匿名 2021/09/09(木) 22:00:00
>>885
でもコロナにかかるよりマシだからワクチンをうったんですよね?その辺りは織り込み済みなのでは?+1
-8
-
2006. 匿名 2021/09/09(木) 22:00:02
>>1743
出てくるソース全てがあやふやなのにすごいよね
関わらないほうが良さそうね…+7
-0
-
2007. 匿名 2021/09/09(木) 22:00:03
3回目のブースター接種が始まれば1回目2回目のワクチン接種権は失効しますよ
3回目からはノババックスやアストラゼネカの旧来型ワクチンが主流になるので
先進的なmRNAワクチンを打てる機会はほぼ喪失します+1
-0
-
2008. 匿名 2021/09/09(木) 22:00:07
>>1869
「重症化しない」じゃなくて抗体がある数ヶ月間は「重症化しにくい」だよ
+22
-0
-
2009. 匿名 2021/09/09(木) 22:00:09
>>966
わかります。小さい子供がいるので摂取後の副反応や亡くなっている方がいるという点はずっと気になっています。
なので近場の予約が取れないからと簡単に諦めているところもあります。
とは言え両親や妹、同僚や友人など身近な人たちの摂取が続々と進んでいるので自分もやらなきゃな〜とは思っています。+3
-2
-
2010. 匿名 2021/09/09(木) 22:00:26
>>1854
クルーズとリパのソーマ![尾身氏、ワクチン3回目検討提案 宣言解除後の緩和に慎重求める]()
+8
-1
-
2011. 匿名 2021/09/09(木) 22:00:27
>>1956
ごめん勘違いしてた、様子見派以外のって書いてたね+0
-0
-
2012. 匿名 2021/09/09(木) 22:00:32
>>1993
スモールライト開発できるならコロナ治療薬なんて余裕やろwww+2
-0
-
2013. 匿名 2021/09/09(木) 22:00:36
>>1974
後戻りできないというより、2回打ったら3回打とうと思う人が多いって事じゃない?
ワクチン賛成派なんだから。+24
-0
-
2014. 匿名 2021/09/09(木) 22:00:39
>>1951
細胞性免疫がデルタ相手に段々仕事しなくなる
原因は不明+5
-0
-
2015. 匿名 2021/09/09(木) 22:00:43
>>1668
南極の永久凍土の中で生きている寄生虫もいますよ。+7
-1
-
2016. 匿名 2021/09/09(木) 22:00:45
>>1999
ワクチン強要派ってなんだよwww
常識ありゃ普通打つわ!+12
-20
-
2017. 匿名 2021/09/09(木) 22:00:45
>>1987
脳を支配する何か仕込んであったとか
ワクチン接種した人威圧的になる人多くない?+56
-14
-
2018. 匿名 2021/09/09(木) 22:01:01
>>1213
ワクチンパスポートのトピは結構打った人たちが盛り上がっていたよ
自分たちが優勢で語れない場には来ないんじゃない?+34
-0
-
2019. 匿名 2021/09/09(木) 22:01:05
>>1854
嘘だよ。言ってるのが大学も出てない詐欺師だから。
でも、本は30冊ぐらい出してる。全部アルカリ健康食品について。+3
-3
-
2020. 匿名 2021/09/09(木) 22:01:13
>>1809
死骸を入れる意味あるのかね?
だったら寄生虫って分からない様に出来そな
もんだけどね
+2
-1
-
2021. 匿名 2021/09/09(木) 22:01:17
>>1923
感染予防効果は明らかになってないと書いてあるけど発症予防効果はあると書いてあるね。+1
-0
-
2022. 匿名 2021/09/09(木) 22:01:20
>>1712
それは勉強不足だと思う+3
-3
-
2023. 匿名 2021/09/09(木) 22:01:22
コロナで医師会や開業医はボロ儲けしたよね
コロナ患者は見ないけど(病気はコロナだけじゃないを建前に)ワクチン接種の日給20万のバイトには喜んで参加+17
-0
-
2024. 匿名 2021/09/09(木) 22:01:22
>>1902
数ヶ月後には3回目接種券届くのか、て思うと萎えるね。パッケージも消したりなんかな、そもそもいらない。段階的に解除でもういいよ。+3
-0
-
2025. 匿名 2021/09/09(木) 22:01:25
>>2004
う、うん、そーだね+3
-0
-
2026. 匿名 2021/09/09(木) 22:01:28
>>1982
あれ体内に入ると美白効果もあるみたい
アンチエイジングみたいな感じだよ+1
-0
-
2027. 匿名 2021/09/09(木) 22:01:37
予防効果そんなに高くないのにワクチンパスポートおかしくない?無症状で広めるかもじゃん+4
-0
-
2028. 匿名 2021/09/09(木) 22:01:39
>>1977
肥満でない人が8割!?
肥満の方が重症化しにくいのね+1
-1
-
2029. 匿名 2021/09/09(木) 22:01:43
医療従事者です。ワクハラ受けてます。これ以上酷くなるなら仕事辞めようかなって思う。私は頭おかしいのかなぁ。+12
-0
-
2030. 匿名 2021/09/09(木) 22:01:46
>>2007
mRNAだってまだまだ作らてれるのになぜ?+3
-0
-
2031. 匿名 2021/09/09(木) 22:01:48
>>955
全員の前で発表とか…脅迫されてる気分になるよね。
会社の圧力で強制するのはほんと酷いと思う。
任意なのにさ。
私はもう接種済みだけど、感染予防対策を続けてるし、出来る限り自粛するつもり。
打たない選択をし辛くなってる世の中の空気はマジでおかしいよね。
+30
-0
-
2032. 匿名 2021/09/09(木) 22:01:56
>>2006
3回目にチャレンジですねw+5
-1
-
2033. 匿名 2021/09/09(木) 22:01:57
>>1299
20年ぐらいネットやってるけど特になにも気づかないんだけど。
昔はネットに真実があってテレビは嘘ばかりと思ってけど
今はネットも相当いい加減だと思ってる。+18
-12
-
2034. 匿名 2021/09/09(木) 22:01:59
>>1980
何色だった?+0
-0
-
2035. 匿名 2021/09/09(木) 22:01:59
>>618
不満はある!疑問はない!バカだから!
色々調べてる。色々情報がありすぎて処理できない。
本気のバカは本当にわからなくて聞いてるだけです。+30
-2
-
2036. 匿名 2021/09/09(木) 22:02:00
>>1993
それお医者さんに聞いてきてwww実況してほしいww+0
-0
-
2037. 匿名 2021/09/09(木) 22:02:04
>>2007
アストラゼネカってmRNAではないと聞いたけど、本当にそうなの?
たまにがるちゃんでアストラゼネカの方が安全って言っててマイナスくらってるけど、mRNAが不安な人はそうだろうね。+2
-0
-
2038. 匿名 2021/09/09(木) 22:02:04
私の家族、旦那の家族はみんなワクチン打ってます
ですが、旦那の親も私の親も私にはワクチン打つな!って言ってきます
私がアレルギー多数持ちにアトピーに喘息持ちだから+10
-0
-
2039. 匿名 2021/09/09(木) 22:02:14
>>1
もういいかげんに やめてほしい!+11
-0
-
2040. 匿名 2021/09/09(木) 22:02:16
>>2017
あなた頭の病気かなんかなの?+9
-16
-
2041. 匿名 2021/09/09(木) 22:02:20
>>760
毎日見てますよ。
シカ先生の病院が近所にあったら良かったのになぁ。と動画見ながら思っています。
大丈夫ですから。の言葉が心強いです。+15
-0
-
2042. 匿名 2021/09/09(木) 22:02:36
今初めて尾身さんのインスタ見たけど凄い事になってて笑ったわ。
頼むからイスラエルの現状を把握して勉強してくれよと思う。+24
-0
-
2043. 匿名 2021/09/09(木) 22:02:42
>>1983
ほんとそれ
テレビ消して新聞読まなかったら、なんにも怖いこと起こってない、2019年までと変わってないって気づくと思うんだけどね
道路でバタバタ人が倒れて死んでるとかなら、言われなくても怖くて閉じこもるよ+30
-1
-
2044. 匿名 2021/09/09(木) 22:02:45
>>1712
オカルトって言うか、何言ってんのかさっぱり。+2
-0
-
2045. 匿名 2021/09/09(木) 22:02:46
>>1911
打て打ての人達ってやたら詳しいよね。しかも5Gだのチップだのわざとバカそうなのだけ持ち出して来るの。ワクチンで沢山亡くなってるとか被害が出てる事実は無視。
しかもわざわざ自然派ママ?達のツイッターとかまで探して、おかしいwwと断定して拡散してたりして不気味。
どっちがイカれてんだかね。+10
-1
-
2046. 匿名 2021/09/09(木) 22:02:53
>>2016
普通ってなによ+7
-5
-
2047. 匿名 2021/09/09(木) 22:02:56
>>2023
PCRに行列はまだ続くだろうし
何なんだろ、て思うよ
どんだけ医療製薬界に税金や金流れるんだろ?しかも、いらんとこに+11
-1
-
2048. 匿名 2021/09/09(木) 22:03:00
>>2030
これから変異株向けの治験しなおしだから、新型はしばらく使えないよ+0
-0
-
2049. 匿名 2021/09/09(木) 22:03:06
ワクチン打たなくても良い気がしてきたなぁ。
なんかもう情報過多で色々いや!+18
-0
-
2050. 匿名 2021/09/09(木) 22:03:14
職場でワクチン打ってない人の名前一覧が張り出されてます。
これ最低ですよね?
もう私追放されるのかな。+24
-1
-
2051. 匿名 2021/09/09(木) 22:03:20
>>2043
そーだねーそーだねー+2
-1
-
2052. 匿名 2021/09/09(木) 22:03:20
ワクチン打たない人ずるいよね
先に打った人がどうなるか様子みてるなんて酷すぎる
何かある時はみんな道ずれにしないと不公平+2
-27
-
2053. 匿名 2021/09/09(木) 22:03:23
>>1669
どこに入れてももう無理だって+0
-3
-
2054. 匿名 2021/09/09(木) 22:03:25
尾身よ、先に132億ぼったくりを片付けてから
次の提言へどうぞ+27
-0
-
2055. 匿名 2021/09/09(木) 22:03:29
>>1798
あなたに会うのはこれで四度目
普段はオカルトも陰謀論も信じないけどあなただけはなぜかすごく気になる
信じたくなってしまう
松葉茶、接種済みの親に送ることにしようかな+5
-0
-
2056. 匿名 2021/09/09(木) 22:03:31
>>1976
違う。例のギリシャ人の社長+0
-0
-
2057. 匿名 2021/09/09(木) 22:03:35
>>2042
どんな感じなの?+1
-0
-
2058. 匿名 2021/09/09(木) 22:03:36
>>1974
素人の私見で申し訳ないけど、私なら一回でやめとくな。蜂に刺されるの2回目の方がやばいでしょ。
超大雑把に言うとそういうことだと思ってる。
2回目打った人も若さがある人はワクチンではなく、免疫を上げる努力と、治療薬で対処した方がいいような気がする。
イベルメクチンも予防効果あるみたいだから半年に一回くらい飲んどくかな。
オバハンのしょーもない話でした。+56
-10
-
2059. 匿名 2021/09/09(木) 22:03:39
>>2010
マジ?ホウライエソは?+0
-0
-
2060. 匿名 2021/09/09(木) 22:03:49
全部中国のせい+8
-0
-
2061. 匿名 2021/09/09(木) 22:03:50
>>2056
ソース知りたい+0
-0
-
2062. 匿名 2021/09/09(木) 22:03:58
>>457
全然陰謀論じゃなくて事実に基づいてのワクチン批判だったんだね…
スパイク細胞を攻撃させるのは人類史上初だって言うし、今後どうなるかわからない。+184
-1
-
2063. 匿名 2021/09/09(木) 22:03:59
>>2052
どっちの人?+1
-2
-
2064. 匿名 2021/09/09(木) 22:03:59
>>1781
冷凍することに意味があると思いますよw+6
-0
-
2065. 匿名 2021/09/09(木) 22:04:05
>>2060
それは言ってはいけない+0
-4
-
2066. 匿名 2021/09/09(木) 22:04:07
>>2050
タマホームに転職しなさい+12
-1
-
2067. 匿名 2021/09/09(木) 22:04:13
これが陰謀論だと笑えない状況になってきている気がして怖い+18
-0
-
2068. 匿名 2021/09/09(木) 22:04:14
>>2011
こちらこそ、文章が少し読みにくくてごめんなさい
私も読み間違えて反対の意見を言ったことがあるわ
何度投稿したコメントを削除したくなったことか 笑+0
-0
-
2069. 匿名 2021/09/09(木) 22:04:30
>>1991
すごい!+0
-0
-
2070. 匿名 2021/09/09(木) 22:04:31
ふと気になって調べたら全世界でコロナ死者たったの440万なのかよ。イメージで1億とか行ってるのかと思ったら大した事無さすぎて草+17
-5
-
2071. 匿名 2021/09/09(木) 22:04:36
>>2035
そんなあなたにムーンショット+15
-1
-
2072. 匿名 2021/09/09(木) 22:04:38
>>2028
記事読んだ?20代以下では50%となってたよ
基礎疾患については書いてなかったけどハイリスクなのは間違いない+1
-0
-
2073. 匿名 2021/09/09(木) 22:04:39
>>2060
殺傷能力の高い東京株は日本が発祥+1
-3
-
2074. 匿名 2021/09/09(木) 22:04:58
本当にmRNAワクチン、やばいものだったんだな
政府、マスコミが一丸となって打たそうとしてる。
マジでおかしいわ。どうしたんだよこの国。+51
-0
-
2075. 匿名 2021/09/09(木) 22:05:05
>>2029
いや正常だと思います。+5
-0
-
2076. 匿名 2021/09/09(木) 22:05:12
とにかく治験が終わるまでは打たない。
+13
-0
-
2077. 匿名 2021/09/09(木) 22:05:26
>>1720
やはり!
ワクチンに疑問を持たないで、さっさと打つのは学士、修士の普通の人(大卒・院卒)が多くて、ワクチン懐疑派は、あなたのような博士レベルか高卒以下が多いって聞いたことある!
高卒以下ってのも極端な表現だけど、ある意味生きる力に優れているとか。+1
-6
-
2078. 匿名 2021/09/09(木) 22:05:35
5Gどうやって撤去できる?
イギリスは5Gできたとき電信柱倒して壊してたけど、あれが正解?+7
-1
-
2079. 匿名 2021/09/09(木) 22:05:35
>>1918
めっちゃ救われた
ありがとう😭スクショしてたまに見返す😭+12
-0
-
2080. 匿名 2021/09/09(木) 22:05:37
最初に打った人が3回目のころ やっと1回目って人も出てくるよね。+0
-1
-
2081. 匿名 2021/09/09(木) 22:05:37
>>2048
まぁ、変異株に効果ないなら別にいらないもんね+5
-0
-
2082. 匿名 2021/09/09(木) 22:05:51
>>2050
バカ一覧を作ってるだけだからいいんじゃね?
会社にとって不要な人ばかりだろうし+2
-11
-
2083. 匿名 2021/09/09(木) 22:05:54
>>1968
いやmRANワクチンに懐疑的な話してたから、他のワクチンはどう思ってるのかなーって+0
-0
-
2084. 匿名 2021/09/09(木) 22:05:55
>>2029
おかしくない
まとも+8
-0
-
2085. 匿名 2021/09/09(木) 22:05:58
>>1781
頭悪過ぎて変な菌もらいそうだから成敗!+0
-6
-
2086. 匿名 2021/09/09(木) 22:06:03
>>1982
深海魚の一種だよ
体長35cm歯鋭くて怖い顔してるよ
画像貼ろうと思ったけど嫌がる人いそうだから止めるわ+1
-0
-
2087. 匿名 2021/09/09(木) 22:06:13
>>42
イスラエルはワクチン接種したらマスク外しokにしたからでは?+21
-21
-
2088. 匿名 2021/09/09(木) 22:06:21
めっちゃ無駄 買いたく無い
![「陰性証明」に簡易キットを活用する方針 西村大臣、市販検討求める(朝日新聞デジタル) - Yahoo!ニュース]() 「陰性証明」に簡易キットを活用する方針 西村大臣、市販検討求める(朝日新聞デジタル) - Yahoo!ニュースnews.yahoo.co.jp
「陰性証明」に簡易キットを活用する方針 西村大臣、市販検討求める(朝日新聞デジタル) - Yahoo!ニュースnews.yahoo.co.jp新型コロナウイルス対策の行動制限を今秋にも緩和すると政府が打ち出したことをめぐり、西村康稔経済再生相は9日、ワクチン未接種の人向けに発行する「陰性証明」にPCRに加え抗原検査の簡易キットも活用する
+4
-0
-
2089. 匿名 2021/09/09(木) 22:06:23
>>1551
イベル◯クチンは発熱してPCR陽性になってから飲むものです。+0
-3
-
2090. 匿名 2021/09/09(木) 22:06:25
>>16
まさに今日1日死んでた。
こんなに辛いなら3回目は怖くて打ちたくない…😭+25
-1
-
2091. 匿名 2021/09/09(木) 22:06:26
>>2014
お得意の科学で解明したら?
そんな事もわからずによくワクチンなんて開発出来るね
科学って本当に意味あるのかな?+0
-2
-
2092. 匿名 2021/09/09(木) 22:06:33
もう私のまわりでは、え?打たないんだ、へぇーみたいな感じで軽く距離おかれてる感じ+4
-1
-
2093. 匿名 2021/09/09(木) 22:06:35
>>2062
陰謀論が出てる段階で打つのは躊躇うわ。+38
-0
-
2094. 匿名 2021/09/09(木) 22:06:44
>>2032
もちろん+3
-0
-
2095. 匿名 2021/09/09(木) 22:06:46
>>1999
この会話の流れでワクチン強行派になる意味が分からないw
これだから反ワクはって言われるんだよ。自覚しようね+10
-7
-
2096. 匿名 2021/09/09(木) 22:06:46
>>1895
サナダムシダイエットって前に話題になったね+0
-0
-
2097. 匿名 2021/09/09(木) 22:06:58
>>1983
スーパーの惣菜のポテトサラダが腐ってても大騒ぎするこの日本でやで!+15
-0
-
2098. 匿名 2021/09/09(木) 22:06:59
>>2074
おかしいのはあなたでしょw+1
-18
-
2099. 匿名 2021/09/09(木) 22:07:05
>>1927
ワクチン系のトピで初めて笑ったかも+3
-0
-
2100. 匿名 2021/09/09(木) 22:07:22
ワクチンパスポートないと入れないお店とか行けない場所とか増えると、何で打たないの?って、打った彼氏とか友達、家族と言い合いになるのかなあと想像してみたりしてる。でも、打ちたくないのよねー。+6
-1
-
2101. 匿名 2021/09/09(木) 22:07:23
>>2052
釣りっぽいなー+9
-1
-
2102. 匿名 2021/09/09(木) 22:07:25
>>1773
酸化グラフェンは酸化亜鉛だから、人間の持つ力で分解・排出できる。
水や抗酸化力の高いものをたくさん飲んで血液をきれいにする。+3
-1
-
2103. 匿名 2021/09/09(木) 22:07:26
>>2043
あなたはついでにガルも閉じないと
コロナやワクチントピばっかりじゃん+1
-2
-
2104. 匿名 2021/09/09(木) 22:07:29
>>509
ん?接種率60%だけど?+6
-9
-
2105. 匿名 2021/09/09(木) 22:07:29
>>1991
楽しそう笑+2
-0
-
2106. 匿名 2021/09/09(木) 22:07:33
>>2019
カオスwww+1
-0
-
2107. 匿名 2021/09/09(木) 22:07:40
菅さんやめるなら、尾身も道連れにしてほしかった、
+26
-1
-
2108. 匿名 2021/09/09(木) 22:07:47
>>2095
黙りなよ嘘偽り捏造ワクチン強要派+2
-4
-
2109. 匿名 2021/09/09(木) 22:07:48
みんなようやく気付き始めてきたw+27
-1
-
2110. 匿名 2021/09/09(木) 22:07:56
>>2077
周り高卒いっぱいいる環境だけどみんな打ってたよ。
中卒以下なんじゃ?+2
-3
-
2111. 匿名 2021/09/09(木) 22:08:04
おもしろいと思ってんのかなー
現実逃避で笑いに逃げて、見なかったことにしてるんだろーな。
そういや、お笑い芸人とかも煽り酷いよね。
前から嫌いだけど、ますます信用ならんくなったわー
シレッとマスクすらせずテレビ出て、コロナは怖い!みんな気をつけろ、自粛しろ!
よー言うわ+6
-0
-
2112. 匿名 2021/09/09(木) 22:08:08
>>2089
予防的に飲んでる人もいますが+6
-5
-
2113. 匿名 2021/09/09(木) 22:08:08
>>2063
そっちの人+0
-0
-
2114. 匿名 2021/09/09(木) 22:08:09
>>2050
うわ、最低な職場だね。
低レベル過ぎ、そういうの辞めましょうとか言ってるよね。本当分科会やワイドショーの奴らが分断煽って馬鹿が乗ってる感じ。
違和感覚えないのは言われるままに3回目打てばいい
どうせすぐ4回目とか言い出すから。+18
-2
-
2115. 匿名 2021/09/09(木) 22:08:11
>>2052
後学のために。こういう時はじっくり様子見をするのが最善の策です。+22
-0
-
2116. 匿名 2021/09/09(木) 22:08:12
理化学研究所は言う『コロナ毒チン接種者は変異株で全員死にまっせ~、自然免疫だと余裕でっせ~!!』
![理化学研究所は言う『コロナ毒チン接種者は変異株で全員死にまっせ~、自然免疫だと余裕でっせ~!!』 | 新・新米社長の備忘録]() 理化学研究所は言う『コロナ毒チン接種者は変異株で全員死にまっせ~、自然免疫だと余裕でっせ~!!』 | 新・新米社長の備忘録ameblo.jp
理化学研究所は言う『コロナ毒チン接種者は変異株で全員死にまっせ~、自然免疫だと余裕でっせ~!!』 | 新・新米社長の備忘録ameblo.jp理化学研究所は言う『コロナ毒チン接種者は変異株で全員死にまっせ~、自然免疫だと余裕でっせ~!!』 | 新・新米社長の備忘録理化学研究所は言う『コロナ毒チン接種者は変異株で全員死にまっせ~、自然免疫だと余裕でっせ~!!』 | 新・新米社長の備忘録新型コロ...
+5
-2
-
2117. 匿名 2021/09/09(木) 22:08:17
ワクチンの件で家族と価値観が合わず疎遠になりそうだわ。
まあ元々そこまで仲良く無かったしどうでもいいけど。+10
-1
-
2118. 匿名 2021/09/09(木) 22:08:17
>>441
ファイザーでアレルギー体質の夫は接種30分後にアナフィラキシー起こして上半身が蕁麻疹だらけになったよ。
救護室で手当てされて問題なかったけど我慢しないでちゃんと伝えたほうがいい。+51
-0
-
2119. 匿名 2021/09/09(木) 22:08:21
>>1781
南極の永久凍土の中で生きている生物もいる。+6
-0
-
2120. 匿名 2021/09/09(木) 22:08:26
>>2023
日本の都市部って外国と比べても病院の数多いのにすぐ医療逼迫するのって、公的病院や公立病院が異常に少なくて民間病院ばっかだからなんだって
国や都府県が病院建てようとすると、医師会が大反発するから建てられない
だから国を挙げて動かなきゃならない有事が起こると非常に脆弱になる+9
-0
-
2121. 匿名 2021/09/09(木) 22:08:32
コロちゃんのアップデートにワクチン効果が追い付いてないよね。。
人類は負けるのかしら?(*´・ω・`)ノ+1
-2
-
2122. 匿名 2021/09/09(木) 22:08:35
>>2046
まぁまぁ、ガルちゃんやってたらみんな同じよ+0
-3
-
2123. 匿名 2021/09/09(木) 22:08:37
>>2076
あと20年だっけ?
私もそれ終わったら打つ+7
-0
-
2124. 匿名 2021/09/09(木) 22:08:44
>>2034
色ワロタw+2
-0
-
2125. 匿名 2021/09/09(木) 22:08:48
>>2028
BMI30はとんでもないデブだよ
25以上が肥満+1
-0
-
2126. 匿名 2021/09/09(木) 22:08:49
こえーよ。打たなきゃよかった。
報道もおかしいよ。打たそうとする方向にもっていこうとしてるじゃん+35
-0
-
2127. 匿名 2021/09/09(木) 22:09:07
>>2026
どこに書いてるの?+0
-0
-
2128. 匿名 2021/09/09(木) 22:09:12
>>2121
イータ出たね
いやん+0
-0
-
2129. 匿名 2021/09/09(木) 22:09:16
>>2121
自然免疫も追いついてない
人類を根絶させるまでコロナは変異し続ける+3
-1
-
2130. 匿名 2021/09/09(木) 22:09:18
>>1564
えっ(T-T)+43
-0
-
2131. 匿名 2021/09/09(木) 22:09:20
打てワク
ワクチン推進強要派が湧き出してきたね〜w+7
-0
-
2132. 匿名 2021/09/09(木) 22:09:21
>>2107
ホント!何で一緒にいなくならんの?しかも、もはや自分が首相かのようなふるまいじゃない?+6
-1
-
2133. 匿名 2021/09/09(木) 22:09:32
>>1990
メリットに対してデメリットの方が大きすぎない?+41
-2
-
2134. 匿名 2021/09/09(木) 22:09:33
気持ち的には打ちたくない方に傾いてるけど、肥満で重症化リスクあるから打たざるを得ない…。
太ってる自分が悪いんだけどさ。+3
-2
-
2135. 匿名 2021/09/09(木) 22:09:33
知り合いの50代3桁超えた肥満喫煙者ペースメーカーワクチン無しでデルタ株感染でかなりの軽症で済んだ人いるよ
絶対に重症化か死亡と思ったのに+6
-0
-
2136. 匿名 2021/09/09(木) 22:09:36
>>2074
陰謀論信じてなかったけど
それに近づきつつあるよね
とりあえず永遠に様子見だわ+38
-0
-
2137. 匿名 2021/09/09(木) 22:09:38
>>2107
それこそが花道だよね。何したんだろうこの人。+5
-1
-
2138. 匿名 2021/09/09(木) 22:09:43
>>2058
>イベルメクチンも予防効果あるみたいだから半年に一回くらい飲んどくかな。
↑本当?!?!
それも怖くない?+23
-2
-
2139. 匿名 2021/09/09(木) 22:09:45
>>1929
だいたいTwitterか、よくわからない海外のやつだね。+1
-1
-
2140. 匿名 2021/09/09(木) 22:10:01
>>1247
これ怖い
着実に近づいていってる+15
-1
-
2141. 匿名 2021/09/09(木) 22:10:06
>>1922
茶番だよ茶番❗はよ尾身さん例の件も記者会見して‼️![尾身氏、ワクチン3回目検討提案 宣言解除後の緩和に慎重求める]()
+28
-1
-
2142. 匿名 2021/09/09(木) 22:10:16
>>1785
その通り。
ワクチンは筋肉に打ってるから金属が入っていても大丈夫とかいう人もいてびっくり。
ワクチン成分はすべて毛細血管に取り込まれて血管を通って全身に回るのに。。。
生物の授業もなくなったの????ってびっくりした。+78
-1
-
2143. 匿名 2021/09/09(木) 22:10:18
直後にしんでも因果関係不明なのでワクチン接種での死亡者はゼロ
永遠のゼロ+24
-1
-
2144. 匿名 2021/09/09(木) 22:10:20
>>2023
ボロ儲けしてたのは尾身ってここで見たけど?+7
-0
-
2145. 匿名 2021/09/09(木) 22:10:27
>>1536
それはまた別の話なんじゃないかな💦
・スパイクタンパクに作用してACE2との結合阻害ができる可能性
・増殖を阻害できる可能性(プロテアーゼ阻害)
・抗炎症作用→サイトカインストームを防ぐ可能性
とかだったような
あくまで全て可能性で本当に有効かは臨床試験の結果見ないとわからないだろうし、ウイルスとの相性やその用法用量でどんなAEが出てくるかも治験次第なんだろうけどね+3
-1
-
2146. 匿名 2021/09/09(木) 22:10:42
ファイザーだけど2回目の副反応すごすぎてもう打ちたくない。+7
-0
-
2147. 匿名 2021/09/09(木) 22:10:44
ワクチンで重症化は防げるけど、コロナの後遺症も防げるんでしょうか+1
-1
-
2148. 匿名 2021/09/09(木) 22:10:44
>>1895
大昔の歌姫マリアカラスがやってたよね+2
-0
-
2149. 匿名 2021/09/09(木) 22:10:46
>>2099
反ワクこんなもんなんだよな…+2
-5
-
2150. 匿名 2021/09/09(木) 22:10:53
>>1318
これ、ずるい言い方だよね
騙されちゃいけないよ
「受けることはできます(が、何があっても知りません)」というヤツだよね+158
-0
-
2151. 匿名 2021/09/09(木) 22:10:54
>>2112
肝臓やられると思う
普通に危険+7
-2
-
2152. 匿名 2021/09/09(木) 22:10:54
>>1379
視野狭そうだねー
みんなが打つ人みんな何も考えてないみたいな言い方。笑+4
-17
-
2153. 匿名 2021/09/09(木) 22:10:59
>>2115
慌てるナントカは…ってマジなんだな+10
-0
-
2154. 匿名 2021/09/09(木) 22:11:01
ワクチン拒否する人たちって迷惑なんだよね
コロナにかかったら重症化する可能性とか死ぬ可能性がめちゃ高いわけで
医療現場とか式場とか家族とか会社とかいろんなところに迷惑かけるわけよ
自己中なだけってのを早く気づこうね+3
-27
-
2155. 匿名 2021/09/09(木) 22:11:16
1回目打ったけど、2回目は打たなくていいかな?
でもワクチン差別が秋から政府公認で行われるからねー
+3
-1
-
2156. 匿名 2021/09/09(木) 22:11:21
>>2103
打ちたい人は打てばいいと思うよー+14
-0
-
2157. 匿名 2021/09/09(木) 22:11:21
>>1896
そう思う。
あの人達、良心の呵責ないのかと思う。
まさかテレビ出てる人たちが、間違ったことを言うはずないと無条件に信じてる。+19
-0
-
2158. 匿名 2021/09/09(木) 22:11:28
>>2102
そもそも酸化グラフェンが主成分だというソースはあるのでしょうか?探しても怪しい個人ブログしか見当たらないのですが+4
-0
-
2159. 匿名 2021/09/09(木) 22:11:30
>>2113
釣りだね+0
-0
-
2160. 匿名 2021/09/09(木) 22:11:34
>>2116
デマはこうやってできるんだね。+3
-4
-
2161. 匿名 2021/09/09(木) 22:11:36
>>2052
正直でいいと思うわw+0
-0
-
2162. 匿名 2021/09/09(木) 22:11:38
>>2045
なりすましはやめてくださいね。+0
-0
-
2163. 匿名 2021/09/09(木) 22:11:42
>>2125
スポーツ選手は25~29が多いんだって。
筋肉は脂肪より重いからBMIと体脂肪率で肥満を考えるもの。
BMIはあくまで体重で「病気になりやすい」かどうかを見る指標。+3
-1
-
2164. 匿名 2021/09/09(木) 22:11:49
>>2
打ちたくない人も、リスクを背負って打った人もいる。そういう人がメリットを享受したらいけないの?任意だけど社会的に打ってほしい政府が、そういう人にメリットを与えるのは間違いじゃない。好きで打たない人は自粛したらいいと思う+17
-45
-
2165. 匿名 2021/09/09(木) 22:11:53
>>2126
なんかおかしいよね、変だよね、てのが普通の感想だよ。打ち続ける?もう辞退するわ。
パスもいらね。+33
-2
-
2166. 匿名 2021/09/09(木) 22:12:02
>>1813
理解できないことには関われないでしょ。工作員たちは。+2
-0
-
2167. 匿名 2021/09/09(木) 22:12:08
>>2149
自称高学歴上級国民のくせにガル粘着臭+2
-1
-
2168. 匿名 2021/09/09(木) 22:12:08
>>515
第Ⅲ相試験まで終わってるよ。+2
-1
-
2169. 匿名 2021/09/09(木) 22:12:14
9/1から9/3までの感染者42,125人のうち
未接種者・・・ 33,360人
1回接種者・・・ 2,841人
2回接種者・・・ 2,568人
接種歴不明・・・3,356人+3
-0
-
2170. 匿名 2021/09/09(木) 22:12:32
>>1277
1回目の副反応がつらかった人とかは2回目やめて当然だよ
私は接種していないけど接種した人をバカにするのは違うよ
打て打て!と圧力かけたくせに自分は止めた人とかは論外だけど。+48
-1
-
2171. 匿名 2021/09/09(木) 22:12:36
>>2154
勉強してくれたのむからお願いだから
情報が二、三日で化石化するんだよ+21
-1
-
2172. 匿名 2021/09/09(木) 22:12:44
夫婦でコロナやワクチンに対して価値観合わないと離婚になるだろうなって思う。
その部分は合う人でめちゃくちゃ楽だし、本当良かったわ+20
-0
-
2173. 匿名 2021/09/09(木) 22:12:47
>>2160
あなた洗脳されすぎ・・・+4
-2
-
2174. 匿名 2021/09/09(木) 22:12:50
>>2154 ワクチンって強制じゃないから別に良いんでは?あなたの方が自己中にみえる
+25
-0
-
2175. 匿名 2021/09/09(木) 22:12:53
>>2147
重症化までいったらそんなに変わらないらしい
うまく免疫ついてない人が重症化するみたい+3
-0
-
2176. 匿名 2021/09/09(木) 22:12:57
お金って何なんだろうって考えちゃうわ。
そりゃ私もお金好きだけどさ。
お金は人を狂わせに狂わせる。こわいね。+17
-0
-
2177. 匿名 2021/09/09(木) 22:13:01
ここ見ていると山口もえのことあれこれ言えないよね。+0
-0
-
2178. 匿名 2021/09/09(木) 22:13:04
>>2101
わかる、この人打ってない人だと思うな。+1
-1
-
2179. 匿名 2021/09/09(木) 22:13:20
>>515
用量設定は国際治験でやってる+0
-3
-
2180. 匿名 2021/09/09(木) 22:13:22
>>2154
喫煙者に肺がんのリスクあって迷惑だとお伝えしてる?
大食いの人に成人病のリスクあって迷惑だってお伝えしてる??
なんでコロナだけムキになってるの?+24
-0
-
2181. 匿名 2021/09/09(木) 22:13:26
>>1929
じゃあ逆に治験中のワクチンの何を信じてるの?
何を参考にしてるの?テレビ?+22
-0
-
2182. 匿名 2021/09/09(木) 22:13:28
>>1473
そういわれたら確かにって感じ。
ワクチンの効果がずっと変わらず1年も2年も持続するってなってもそれはそれで怖いってなるんじゃない?笑+7
-11
-
2183. 匿名 2021/09/09(木) 22:13:41
>>2167
なにそれホウライエソの方が面白い+0
-0
-
2184. 匿名 2021/09/09(木) 22:13:43
>>2070
インドは10倍、中国は本当の死者隠してるから、当てにならない数字+6
-0
-
2185. 匿名 2021/09/09(木) 22:13:46
>>1444
三浦瑠麗はわかるとして、山中教授もいるやん。。
はぁ。もう誰を信じていいのやら。
尾身さん、ちんてつろうに国会でやられてた時かばったのに。。+42
-0
-
2186. 匿名 2021/09/09(木) 22:13:49
ワクチン打ちたいやつは勝手に打てよー
こちらに実害出たら全力で争う
それだけ
ワク派文句あるなら来なよ+16
-0
-
2187. 匿名 2021/09/09(木) 22:13:50
>>2164
打ちたくないのに打たされた人は可哀想と思うけど、言われるままに打ち続けるの?
その特典も数ヶ月毎に打たないと取り上げられるんだよ。脱落者だらけになるなら最初から打たないしいらない。+31
-2
-
2188. 匿名 2021/09/09(木) 22:13:54
>>2165
打ち続けるよ。
抗体なくなるのは確実だから。+6
-2
-
2189. 匿名 2021/09/09(木) 22:13:58
>>2017
ワクチン関係なく
コロナ禍でみんなイライラしてる+30
-1
-
2190. 匿名 2021/09/09(木) 22:14:07
>>2171
そういうふうに自分が専門家かなにかみたいに勘違いしてるヤツが一番やっかいなんだよ
頭わるいくせに+4
-4
-
2191. 匿名 2021/09/09(木) 22:14:08
>>2104
2回目打った人が未接種に格下げされたから。2回目ほとんど意味がなくなったからね。格下げ前までは90%+26
-1
-
2192. 匿名 2021/09/09(木) 22:14:13
>>1969
抗体がなくなるって詐欺。
最初は抗体半年続くって話だった。+71
-0
-
2193. 匿名 2021/09/09(木) 22:14:14
>>2017
そのネタもしつこいなぁ+9
-4
-
2194. 匿名 2021/09/09(木) 22:14:16
権力者の中に人類を本気で救おうと思っている人はもういないのですか?
これからは自分しか信じられない世の中になるのでしょうか
人間という生き物が一番怖いです+9
-0
-
2195. 匿名 2021/09/09(木) 22:14:19
>>1990
言い難いですが自分にはメリットだと思ったので打ったけど、言いきれない程様々な事情やリスクを背負ってる人もいるのに統計を取ったり公表したりするのは反対です。
+24
-0
-
2196. 匿名 2021/09/09(木) 22:14:25
>>1286
いや、赤紙と全然違う
接種券なんて開封もせずにどこかにいっちゃったよ+9
-0
-
2197. 匿名 2021/09/09(木) 22:14:26
>>2151
ガルにもいたよ。反ワクチンでイベルメクチン個人輸入して予防で飲んでるって人。+6
-0
-
2198. 匿名 2021/09/09(木) 22:14:28
>>2177
確かにw
ただ、個人的には田中は山口もえと再婚してから
負のオーラが纏わりついてる。+0
-0
-
2199. 匿名 2021/09/09(木) 22:14:39
>>2186
釣り臭いね+0
-0
-
2200. 匿名 2021/09/09(木) 22:14:41
>>2182
いや、他のワクチンは数年持つけどなぁ+9
-1
-
2201. 匿名 2021/09/09(木) 22:14:48
>>2143
しかも治験了解ですokですってサインしちゃってるから。
お気の毒だけど、帰り道や会場で亡くなっても無理なんじゃない?
+21
-0
-
2202. 匿名 2021/09/09(木) 22:14:54
>>2163
若い力士コロナで死んだよね+2
-3
-
2203. 匿名 2021/09/09(木) 22:15:03
>>1472
入ってないよ
ワクチンの保管温度考えてみ+11
-5
-
2204. 匿名 2021/09/09(木) 22:15:06
>>2181
自分の直感だよ
報道は一切信じてない+14
-3
-
2205. 匿名 2021/09/09(木) 22:15:07
>>1591
その前に歯石とって欲しい。+12
-0
-
2206. 匿名 2021/09/09(木) 22:15:09
>>2116
しまった。クリックしてしまった。
広告バナー貼ってあるじゃん。なんだこれw+2
-0
-
2207. 匿名 2021/09/09(木) 22:15:12
>>2164
残念だね。
パスは3回目じゃないと意味ないみたいよ+10
-1
-
2208. 匿名 2021/09/09(木) 22:15:13
>>2153
安全性を確認せずに焦っても仕方ないのにねw散々ワクチン推奨派から陰謀論を信じているあたおかだとバカにされましたけどじっと耐えてましたw+20
-0
-
2209. 匿名 2021/09/09(木) 22:15:21
>>2126
私は打ってないけど、2回打った人達、どうして怒らんの?又打つ気なのかな?
金属片も死人まで出てるのに流されつつあるし、何でみんな怒らないの?私、打ってたらブチ切れるけど。3回目だと!?はあああ!?って。+36
-3
-
2210. 匿名 2021/09/09(木) 22:15:23
>>2164
ワクチン義務でも強制でもないよ
希望者だけだから+37
-0
-
2211. 匿名 2021/09/09(木) 22:15:27
>>2192
抗体少なくても記憶してるらしいよ
ガルちゃんより記憶力よさそ+6
-17
-
2212. 匿名 2021/09/09(木) 22:15:33
>>2190
自己紹介おつかれ+1
-1
-
2213. 匿名 2021/09/09(木) 22:15:39
>>446
何様+4
-28
-
2214. 匿名 2021/09/09(木) 22:15:39
さっきテレビで
ミュー株にはワクチンの効果がないそうです→ワクチンを早く打ちましょう
こんな日本語ありか?+57
-0
-
2215. 匿名 2021/09/09(木) 22:15:48
>>2188
酷い副反応に当たったら、そんなこと言えなくなる。+8
-1
-
2216. 匿名 2021/09/09(木) 22:15:53
>>2138
アフリカの人は国から配られて予防で毎年飲んどるお馴染みの薬やで
+8
-1
-
2217. 匿名 2021/09/09(木) 22:16:12
>>1794
怖いね
私のかかりつけは小児科もやってるけど先生はワクチン打つか聞いたら
「あんなよく分からないワクチンまだ僕は打たないよ!怖いしね」
って言ってた
だから患者が打ちたいって言ったら
「基礎疾患かあったりどうしてもって言うなら打つけどおすすめはしないよ…?」
って
前にそれを別のトピで話したらワクチン推奨派さんに
「ヤブ医者じゃん!可愛そう笑」
ってめちゃくちゃバカにされたよ
私はその先生のが信用できると思ってるけどね+156
-4
-
2218. 匿名 2021/09/09(木) 22:16:14
>>50
SARSの対策の時から有名だし歴史に残ってるよ。尾身さんも若かったな〜あの頃は。+2
-12
-
2219. 匿名 2021/09/09(木) 22:16:20
>>2185
研究者は政府の要請のインタビューは断れない
三浦は知らない+11
-0
-
2220. 匿名 2021/09/09(木) 22:16:21
>>1943
もう身内で打ってないの私だけだから、変な人扱いされてるけど開き直ってる。いくらお前は変わってるって言われたって打つ気にはなれないもん今は+19
-0
-
2221. 匿名 2021/09/09(木) 22:16:27
>>1616
暴動起こしたいよ本当に
+19
-0
-
2222. 匿名 2021/09/09(木) 22:16:28
5chとかツイッターとか他のSNSとか掲示板みても、
ワクチンを拒否する人なんてまったく見当たらない
反ワクチンなんて言葉も聞かないし
ガルちゃんは異常だよ
カルトというかオカルト+11
-24
-
2223. 匿名 2021/09/09(木) 22:16:29
>>2184
それにしても億には達してないだろうね+0
-0
-
2224. 匿名 2021/09/09(木) 22:16:32
>>2154
めちゃ高い?
あんたの方が迷惑だわ+10
-0
-
2225. 匿名 2021/09/09(木) 22:16:45
>>1473
インフルエンザワクチン効果無いよ。打った人がインフルエンザばら蒔いてるし。
あとモデルナが遺伝子ワクチンでインフルエンザワクチン作ってるから気をつけて。+34
-8
-
2226. 匿名 2021/09/09(木) 22:16:53
>>2138
「馬用」はやめたほうがいいよ+17
-0
-
2227. 匿名 2021/09/09(木) 22:16:53
>>2154
葬儀会社はウハウハやん+6
-1
-
2228. 匿名 2021/09/09(木) 22:16:56
>>2164
打たないんだから、パスポートなんて大したことないもので騒がないでしょう+7
-1
-
2229. 匿名 2021/09/09(木) 22:16:59
>>1871
絶対打ちませんよ。
何故なら、全てを知ってるから。今後のシナリオも。
偽物を打って、打ちましたー!ってアピールして国民に打たせてるだけ。+16
-3
-
2230. 匿名 2021/09/09(木) 22:17:04
>>7
麻痺してきてる。
ずっと打ち続ける気かな。
アレルギー&アトピー持ちで
打つのがこわい..。
感染するのもこわい..
どーしたらいいのー+104
-3
-
2231. 匿名 2021/09/09(木) 22:17:05
>>2214
7分の1って見たよ。誰か夕方のニュース見てた人居る?
なんだこれ、て思った笑
数ヶ月もしないで更に激減するし+24
-0
-
2232. 匿名 2021/09/09(木) 22:17:09
>>2173
そうか?
洗脳されてるのあなたやん。
リンク先の記事は理化学研の記事を引用してもっともらしくしてるけど、内容はデマだよ。
+2
-0
-
2233. 匿名 2021/09/09(木) 22:17:11
>>2223
億単位で減らないと人口削減は失敗なんだよね+4
-0
-
2234. 匿名 2021/09/09(木) 22:17:13
>>1822
総合病院にいるけれど時間短縮と早く帰らせるため子供が小児科でインフル+だとお母さんも検査しましょうかって言う事もある+10
-0
-
2235. 匿名 2021/09/09(木) 22:17:13
>>2209
打ってないんだから怒るなって+4
-4
-
2236. 匿名 2021/09/09(木) 22:17:21
>>618
結局そんな感じの事ばっかり言ってる+31
-1
-
2237. 匿名 2021/09/09(木) 22:17:30
>>2154
打たない人には打たない理由があるんじゃね?私、仲良い子打たないけどそんなこと思わないよ。+9
-0
-
2238. 匿名 2021/09/09(木) 22:17:31
>>2215
熱が42度だっけ?
後遺症残りそうだよね+5
-0
-
2239. 匿名 2021/09/09(木) 22:17:43
>>2190
普通にネット記事にでてる
三回目ブースター接種したら高齢者でも一割り死ぬ
おみはそれをやれと言ってるアタオカ
そういう情報をしっているのかお前は+5
-4
-
2240. 匿名 2021/09/09(木) 22:17:46
ワクチン接種したくても出来ない市町村もありますよね。
京都市のアストラゼネカのワクチンは今日時点で300人分余っています。
40歳以上対象のアストラゼネカだけど。
渋谷の会場では若い人がワクチン接種したくて
あんなに並んでたのにバランスおかしいですよね。+2
-0
-
2241. 匿名 2021/09/09(木) 22:17:51
>>1183
ゴメン、ファイザーも沢山人が亡くなってるし重篤な副反応出てるんだけど。mRNAワクチンなら皆同じよ。
なんで打つor打たないしか選択肢がないんだろ。
もう少し様子見する、もあるのに。
まぁ貴方が後悔しないなら打っても打たなくてもどっちでも良いんじゃない?+13
-0
-
2242. 匿名 2021/09/09(木) 22:17:59
>>2158
横からごめんですが、こんな動画ありますよ。
主成分とは言ってませんが。というか、誰も主成分なんて言ってなくないですか?
+1
-2
-
2243. 匿名 2021/09/09(木) 22:18:00
>>2160
自己免疫力最強は事実でしょw+11
-1
-
2244. 匿名 2021/09/09(木) 22:18:07
>>1987
喫煙者が禁煙して嫌煙家になったのと同じ理屈じゃない?+20
-0
-
2245. 匿名 2021/09/09(木) 22:18:08
>>1884
何がデマでしたか?どれ?+0
-0
-
2246. 匿名 2021/09/09(木) 22:18:12
>>1617
夫も教員ですが、打ってない。職場の同僚の方が復帰出来なくて、絶対打たないと言う先生も数名増えました。
副反応で欠席する子が多くて、何をやっているんだろうと言ってる先生達もいるそうです。+43
-0
-
2247. 匿名 2021/09/09(木) 22:18:15
>>2204
疑う事も無く、直感を信じて打ったんだね
素直な人だ+8
-0
-
2248. 匿名 2021/09/09(木) 22:18:24
>>2208
私も元から打たない派?だけど、あたおかだの何言われようとも、別にって感じ。打たないと決めてるし。
しかもそんな暴言しか吐けないなんて、迷ってるような人達からも怪しまれるだけだと思うw+8
-0
-
2249. 匿名 2021/09/09(木) 22:18:26
>>995
あなたも突然こわいw
落ち着いてw
+1
-6
-
2250. 匿名 2021/09/09(木) 22:18:34
>>2077
別に学歴と明確な相関があるとは思ってないけど、アカデミックの人はシンプルな一本線のグラフだけで1時間でも2時間でも議論できる(したがる)イキモノだから、公表されてる「安全ですよ」って統計に対して「つっこみ所多すぎだろ」って見てる人が多いとは思う
新しい事象に対しては、基本的に新しい評価指標が必要になってくるのが常
例えば「温度」という事象には「分子の振動」を考慮した指標が必要
今回のコロナはあらゆる時空間変動が詰め込まれた超複雑データ
それを高校レベルで習うシンプルな統計だけで「大丈夫です」なんてナンセンスなんおよ+4
-0
-
2251. 匿名 2021/09/09(木) 22:18:38
とりあえず1300までコメント読んだけどさ、未接種大勝利ってノリにまかせてさすがにデマだろと思う情報にまで結構プラスついているよ
まだ色々と悩んでいる人は一旦落ち着いた方がいいよ+12
-8
-
2252. 匿名 2021/09/09(木) 22:18:50
>>2229
そだね!+3
-1
-
2253. 匿名 2021/09/09(木) 22:18:51
>>279
妊婦とかで打つ人って本当に大丈夫なのかな?洗脳されてるんだろうなと思ってしまう
+177
-8
-
2254. 匿名 2021/09/09(木) 22:18:55
>>234
この動画見たけどすごい慌てっぷりだよね。
「ワクチン打ちますか?」と聞かれて。+44
-0
-
2255. 匿名 2021/09/09(木) 22:18:56
今回のウィルス戦争は我慢忍耐した奴が生き残るんだよ
国の犬みたいに忠実に何でも、はい!分かりました!の奴等はグッバァイ!
抵抗し抗い真実を突き止めた者達だけが生きる!
ビルちゃん、そうゆう人材が欲しかったんだね
あなたはあまりにも偉大過ぎて誰も逆らえないから
+11
-1
-
2256. 匿名 2021/09/09(木) 22:19:04
>>1776
わがままとは思えない。
薬なら当然じゃない?+7
-0
-
2257. 匿名 2021/09/09(木) 22:19:08
>>2253
そだね!+21
-1
-
2258. 匿名 2021/09/09(木) 22:19:13
>>2218
いつまで過去のこと言ってるの。
この人には全くついて行けないよ。+11
-0
-
2259. 匿名 2021/09/09(木) 22:19:14
>>2094
頑張って(๑•̀ㅂ•́)و✧+1
-4
-
2260. 匿名 2021/09/09(木) 22:19:18
いつかは人類も地球も滅びるけど、自然に滅びるまで人間同士力を合わせて平和に生きていけば良いと思うのだけれど、それってやっぱり夢物語なんだね
+9
-0
-
2261. 匿名 2021/09/09(木) 22:19:18
>>2214
・・・もうボロボロやなあ・・+19
-0
-
2262. 匿名 2021/09/09(木) 22:19:25
>>341
性別決めるの男の精子だけど+15
-1
-
2263. 匿名 2021/09/09(木) 22:19:33
>>56
別トピでは鼻ワクチンは安全っていう人いるけど、成分同じなのに何言ってるんだろうって思う。
粘膜から体内に入ることを知らないんだろうか。
次から次へニューワクチンがw+92
-3
-
2264. 匿名 2021/09/09(木) 22:19:37
>>2222
ここ、アスペで変人で、世間からはぶられてる人たちの集まりだから+9
-14
-
2265. 匿名 2021/09/09(木) 22:19:39
>>2229
今後のシナリオ教えて下さい!+2
-2
-
2266. 匿名 2021/09/09(木) 22:19:51
>>279
授乳中の人も大丈夫って医師に言われたけど何の影響も無いのか未来に行って見てきたの?と思う
何をもってして大丈夫なのか教えてほしい+158
-1
-
2267. 匿名 2021/09/09(木) 22:19:52
>>2156
残念でしたー
既に職域接種済み
副反応はあったけど今はピンピンしてるー+2
-6
-
2268. 匿名 2021/09/09(木) 22:19:57
こんなワクチン派と反ワクチン派で分裂して喧嘩している隙に、新型コロナにやられちゃうよ。
みんな、本当の敵は新型コロナです。+13
-5
-
2269. 匿名 2021/09/09(木) 22:20:05
>>2204
私も直感で打つのやめた+23
-0
-
2270. 匿名 2021/09/09(木) 22:20:06
>>247
結局言ってる本人も分かってないんじゃない?笑+100
-11
-
2271. 匿名 2021/09/09(木) 22:20:13
>>1127
あてになるかどうかはわからないけど、先週PCR受けた時に同時にインフルの検査もされたから、インフルの検査もう始まってるところもあるよ+0
-0
-
2272. 匿名 2021/09/09(木) 22:20:16
>>1271
テレビ、新聞は大本営発表だよね。+17
-0
-
2273. 匿名 2021/09/09(木) 22:20:23
>>2052
釣りだと思うけど、そうじゃないのならなぜ打った 自分の為じゃないの?+1
-0
-
2274. 匿名 2021/09/09(木) 22:20:24
ワクチン打つか悩んでるJKです
皆さん詳しいみたいなので教えて下さい
今まで読んだ感じだと
ワクチンの効果は嘘
特にデルタ株に対してはデータが無い
感染予防効果も重症予防効果もない
ワクチンには危険な物質が混ざられている
打つと身体に悪い
これであってますか?
ワクチンの危険性を知ってる人だけ返信お願いします+14
-6
-
2275. 匿名 2021/09/09(木) 22:20:26
>>2154
たぶん、自分が実際に罹患した経験者だから言えるんだけど、TVで恐怖を煽られている程ではなかった。メディアの煽り方だと、本当高い確率で重度の肺炎起こすような取り上げ方だけど、現場は軽症で助かる人もかなり多かったよ。ワクチンは世代によってリスクの考え方も違うし、実際にリスクは違うけど、偏った考え方はせず相手の考えを尊重とは思えない?+9
-0
-
2276. 匿名 2021/09/09(木) 22:20:27
>>10
ほんときなくせ~+25
-0
-
2277. 匿名 2021/09/09(木) 22:20:30
>>1914
数日で排出されますよ。+0
-10
-
2278. 匿名 2021/09/09(木) 22:20:32
>>2268
違うよ、中国だよ+3
-1
-
2279. 匿名 2021/09/09(木) 22:20:33
>>1237
中国産しかつけていないんだが…
どこ情報ですか?
調べないとマズイな+2
-2
-
2280. 匿名 2021/09/09(木) 22:20:37
>>2209
横。
2回打てば安心&今後は打たなくて大丈夫!なんて思ってる、ワクチン接種済みの人はあまり居ないと思うよ。
とりあえず今回は打ったけど、
3回目に差し掛かる時期に、コロナの状況を見ながら…どうするか?様子見なんじゃないか?
実験に参加してくれてる人達なんだよ。私は打たないけど。+16
-2
-
2281. 匿名 2021/09/09(木) 22:20:40
>>2260
無理だよ
性格合わない人が身近でも腐るぐらいいるからね
戦わないと生き残れない+1
-0
-
2282. 匿名 2021/09/09(木) 22:20:43
>>2154
ここは反ワクチンが多そうに見えるけど、実際は打ってない人は、予約が取れなくて打ちたくても打てない人がほとんど。
迷惑扱いはかわいそうだよ。
+6
-2
-
2283. 匿名 2021/09/09(木) 22:20:53
>>51
どこかでワクチンの成分?も変えてるって見たんだけど、流石にそれは根拠のないデマだよね?
確かそれぞれの成分名も載ってたな…+10
-1
-
2284. 匿名 2021/09/09(木) 22:20:57
>>996
なんか予約がかぶってキャンセルしなくて
短期間で4回ワクチン打った50代の人がニュースになってたけど、こわすぎる。
ファイザーとモデルナ混合だし。申し訳ないけど頭弱いのかなって思っちゃった。+53
-0
-
2285. 匿名 2021/09/09(木) 22:20:59
>>1854
トリパノソーマ![尾身氏、ワクチン3回目検討提案 宣言解除後の緩和に慎重求める]()
+2
-1
-
2286. 匿名 2021/09/09(木) 22:21:03
>>1957
てか開発者でもないのに何でそんなことわかるの?
酸化グラフェン入ってたとか言ってる人のことをすんなり信じてるのもよくわからない。
私もワクチンは打ってないけどさすがにそういうのは信じ難いわ。+6
-4
-
2287. 匿名 2021/09/09(木) 22:21:12
>>1929
まぁネットもデマ多いが、ワクチンに関して政府や医師や厚労省に不信感やら矛盾を感じて調べるのは普通で、まあ一般人はネットくらいしかないよね。
調べる時点で、何かしら不安や疑問があるわけで、あーやっぱり自分は打ちたくないないんだって。気持ちが決まるんじゃない?
恋愛でも、
なんか不信感あって色々ネットとか読みあさっていて、何かしらのきっかけで、やっぱり別れた方がいいとか気持ちが決まるとかあるし。
+5
-0
-
2288. 匿名 2021/09/09(木) 22:21:16
>>2262
はいロジハラ+2
-1
-
2289. 匿名 2021/09/09(木) 22:21:24
都市伝説トピに迷い込んだようだ+5
-3
-
2290. 匿名 2021/09/09(木) 22:21:28
>>2222
え?5ちゃんこそ懐疑派が多数じゃんw+16
-3
-
2291. 匿名 2021/09/09(木) 22:21:36
>>1776
入院リスクをさげるから中等症になるリスクも下がるよ+1
-3
-
2292. 匿名 2021/09/09(木) 22:21:48
>>2043
あなた、コロナは茶番の人かー+2
-0
-
2293. 匿名 2021/09/09(木) 22:21:50
すでに打たれた方
2回で死ななくても3回では死ぬ可能性もありますのでお忘れなくー!+6
-2
-
2294. 匿名 2021/09/09(木) 22:21:55
短いスパンでワクチンを打たせる政府怖すぎ。
人を実験台にでもするつもりなのかな。
体がおかしくなりそう。+15
-0
-
2295. 匿名 2021/09/09(木) 22:21:59
>>2129
自己免疫はわりと柔軟だよ
自己免疫を阻害させてしまうワクチンとは別もの+5
-0
-
2296. 匿名 2021/09/09(木) 22:22:03
>>2243
そうそう。山中教授もこっそりデータを出していた
なぜ、メディアは大きく扱わないんでしょうね~+5
-0
-
2297. 匿名 2021/09/09(木) 22:22:12
>>2023
最初は日給そこまで高くなかったんだよ
中川会長が提言して菅さんが受け入れて一気に上がった
勤務医が寝ずに働いてる中で、お金出したら集まるって開業医は本当にクズ+12
-0
-
2298. 匿名 2021/09/09(木) 22:22:13
>>2214
もう失笑レベルだよね+19
-0
-
2299. 匿名 2021/09/09(木) 22:22:18
>>2087
それも少しあるけど
接種者が撒き散らしてるからだよ
+23
-1
-
2300. 匿名 2021/09/09(木) 22:22:23
>>2289
都市伝説の宝庫です+4
-0
-
2301. 匿名 2021/09/09(木) 22:22:27
>>14
わかる。
分科会の提言以外に実際に他にコロナ対策何してくれてるのか知りたいし、最近二木教授干されてるね。+16
-1
-
2302. 匿名 2021/09/09(木) 22:22:29
>>2222
5chとTwitterのどこ見てんだよww
5は専門スレも立ってるわ
打つ打たないの選別もさせずに打て!打て!って頭ファシズムかよ。
NWO全体主義になんて絶対にさせねーから+25
-4
-
2303. 匿名 2021/09/09(木) 22:22:29
>>2264
特定の障害名を差別用語として濫用しないでください+8
-0
-
2304. 匿名 2021/09/09(木) 22:22:33
>>2285
成分表にあったとかいうデマを信じてるの?+2
-2
-
2305. 匿名 2021/09/09(木) 22:22:35
>>457
どーしても多くの人に実験したかったんだろうね。自分がサイコパス開発者だったらそう思うもん。+136
-1
-
2306. 匿名 2021/09/09(木) 22:22:35
>>2196
でも打たない奴は非国民扱い状態っす+2
-4
-
2307. 匿名 2021/09/09(木) 22:22:40
>>987
コロナ肺炎で苦しむくらいならぽっくり逝きたいって思っちゃった+1
-1
-
2308. 匿名 2021/09/09(木) 22:22:42
>>2289
早々に出て行かれ〜い!+0
-0
-
2309. 匿名 2021/09/09(木) 22:22:47
>>2280
なるほど。何回でも打つつもりなんだね。+5
-0
-
2310. 匿名 2021/09/09(木) 22:22:47
ワクチン打たない人って人生が上手く行ってなさそうな人が何故か多いよね
+3
-16
-
2311. 匿名 2021/09/09(木) 22:22:52
>>2017
これみんな言ってるよね…+14
-3
-
2312. 匿名 2021/09/09(木) 22:22:53
>>1947
確かに!
生活保護無職で一日中ここに貼り付いて打て打て工作してる人たち!+3
-3
-
2313. 匿名 2021/09/09(木) 22:23:07
>>2236
キリキリしてんだろうな
逆ギレとはこの事を言います 広辞苑より+9
-1
-
2314. 匿名 2021/09/09(木) 22:23:08
>>2290
近況報告として打ったとかまだとかいう話はあるけど
打つのを拒否している人の話とか見たことないよ
鬼女板とかはどうだか知らないけど+1
-1
-
2315. 匿名 2021/09/09(木) 22:23:17
![欧州当局、アストラ製ワクチン副反応にギラン・バレー症候群追加(ロイター) - Yahoo!ニュース]() 欧州当局、アストラ製ワクチン副反応にギラン・バレー症候群追加(ロイター) - Yahoo!ニュースnews.yahoo.co.jp
欧州当局、アストラ製ワクチン副反応にギラン・バレー症候群追加(ロイター) - Yahoo!ニュースnews.yahoo.co.jp[8日 ロイター] - 欧州医薬品庁(EMA)は8日、英製薬大手アストラゼネカの新型コロナウイルスワクチンの副反応として、極めてまれな神経疾患のギラン・バレー症候群(GBS)を追加したと発表
+7
-0
-
2316. 匿名 2021/09/09(木) 22:23:19
>>2259
きも+2
-0
-
2317. 匿名 2021/09/09(木) 22:23:25
私もこの人は私達庶民と同じ考えを持つ救世主だと期待を寄せていたのだけれど、、
弱者はことごとく裏切られて生き辛い世の中になりましたね+3
-1
-
2318. 匿名 2021/09/09(木) 22:23:28
>>2293
どう死ぬの?
楽に行くならいいんだけど、辛いのは嫌+2
-1
-
2319. 匿名 2021/09/09(木) 22:23:37
>>2311
実際、車で事故起こしてる人とかいるみたい
やっぱり影響ある気がする+10
-4
-
2320. 匿名 2021/09/09(木) 22:23:38
>>2218
SARSも嘘だったりしてね!
+6
-0
-
2321. 匿名 2021/09/09(木) 22:23:39
>>2274
ここにはそんなこと知っている専門家はいません。家族と相談してください+11
-0
-
2322. 匿名 2021/09/09(木) 22:23:40
ワクチン打ってる人って人生が上手く行ってなさそうな人が何故か多いよね+5
-7
-
2323. 匿名 2021/09/09(木) 22:23:43
>>1542
え、電話してキャンセルする+12
-0
-
2324. 匿名 2021/09/09(木) 22:23:47
>>2264
自己紹しても大半からシカトw
可哀想だねw+6
-0
-
2325. 匿名 2021/09/09(木) 22:23:57
>>1536
あなたは飲めばいいよ+1
-0
-
2326. 匿名 2021/09/09(木) 22:23:58
>>2214
それなら自分でよく考えて接種しましょうって言ってくれた方がよっぽど信用できるわ+20
-0
-
2327. 匿名 2021/09/09(木) 22:23:59
>>1935
打ったら?っていうて、反ワクさんに怒られそうだけど、ほんとに万万が一のため受けます、私は。自宅待機なんか耐えらんないし。それに少し出かけたいのが本音。+1
-2
-
2328. 匿名 2021/09/09(木) 22:23:59
>>2222
ツイもごちゃんもうようよいるやん
よくレスバやリプ合戦してるし+7
-0
-
2329. 匿名 2021/09/09(木) 22:24:10
>>2318
我儘言うな+0
-0
-
2330. 匿名 2021/09/09(木) 22:24:13
>>2
兄が打てってうるさいです。
ワクチンの副反応が怖いのもあるけど、1歳児1人で見なきゃいけないから躊躇してるのもあって、「コロナで発熱したら面倒見れないけど、ワクチンで発熱しても面倒はみれるからね」って言ってきてマジうざい。
+104
-8
-
2331. 匿名 2021/09/09(木) 22:24:16
>>2238
精子死滅しそう+0
-0
-
2332. 匿名 2021/09/09(木) 22:24:18
>>2322
え、逆じゃないの?
+4
-2
-
2333. 匿名 2021/09/09(木) 22:24:25
>>2289
都市伝説と分かっててみる分には楽しいさ+5
-0
-
2334. 匿名 2021/09/09(木) 22:24:26
>>2294
ワク後に亡くなる人がいるから、デンマークやオーストリアは一時中断したのに+3
-1
-
2335. 匿名 2021/09/09(木) 22:24:43
何回もうって人間の体がたえられるようなものなのか+1
-0
-
2336. 匿名 2021/09/09(木) 22:24:45
>>2264
引きこもりもいるよ+1
-0
-
2337. 匿名 2021/09/09(木) 22:24:48
>>2243
イスラエルも
自然免疫が最強でした
体に良いものを食べましょう
みたいな結論?だしてたよw
+6
-2
-
2338. 匿名 2021/09/09(木) 22:24:49
>>1616
小泉がレジ袋のプラスチック削減してるのに無駄なアクリル板増やしたよね💦無意味なのに。
しかも感染対策しても飲食店の自粛。![尾身氏、ワクチン3回目検討提案 宣言解除後の緩和に慎重求める]()
+14
-0
-
2339. 匿名 2021/09/09(木) 22:24:49
>>2214
全く無いわけではないから
ミューにも多少効く+0
-10
-
2340. 匿名 2021/09/09(木) 22:25:13
>>2314
ニュー速くらいしか見てないよ。そりゃ打ったって人もいるけど、やばいみたいな意見が多い。5ちゃんて元からそういうとこだし。スタップなんとかも最初から懐疑的だったじゃん?+3
-0
-
2341. 匿名 2021/09/09(木) 22:25:16
私のまわりは未接種の人結構いるよ。
私も身内も祖母以外はしてない。
予約取れない市があるのに、余ってる市もある。
なのに3回目検討はおかしい。
+5
-0
-
2342. 匿名 2021/09/09(木) 22:25:20
>>2319
みたいレベル+4
-5
-
2343. 匿名 2021/09/09(木) 22:25:21
>>2327
うってもでかけられないよ...(⌒-⌒; )やば+2
-1
-
2344. 匿名 2021/09/09(木) 22:25:23
>>2312
そことは一緒にしないで+0
-0
-
2345. 匿名 2021/09/09(木) 22:25:23
>>1794
わたし昨日どっかのトピにも書いたけど
引っ越してきて初めての小児科に昨日行ったら
お母さんワクチン打った?打ったほうが良いよ。ワクチンの副反応で死ぬなんて心配してたら、明日事故で死ぬ可能性のほうが高いよと言われ子供の診察時間より長く説得された
患者が誰も居ない小児科で不気味だったわ
そして、おかしいんだけど子供の耳が痛いから見てほしいと受付で言ったら、耳鼻科に行くようにと言われ、あ、耳鼻科なんだとおもい、そうしますと言ったら先生が出てきて紹介状書くよと。
そのためにわざわざカルテ作ってた。お母さんの負担は無いからねって。これってその病院には後からお金入るってことだよね?
なんか、信頼できる小児科とか医者に出会えるって運だなぁ。グーグルの口コミに書いてあげたい!田舎だからあまり病院無いんだよなぁ+85
-3
-
2346. 匿名 2021/09/09(木) 22:25:25
>>1589
うちも。
私は、かえらない。帰って?嫌味言われてストレスで免疫落ちそう。+28
-1
-
2347. 匿名 2021/09/09(木) 22:25:31
>>2321
あ、そういうのはいらないです+3
-3
-
2348. 匿名 2021/09/09(木) 22:25:36
>>2310
ワクチン打ってる人って言いなりロボットだから人間じゃないよね
自分の意志ないからそうだね
南無阿弥陀仏+4
-0
-
2349. 匿名 2021/09/09(木) 22:25:37
>>2017
アンブレラ社のワクチン打ったの?+7
-0
-
2350. 匿名 2021/09/09(木) 22:25:41
>>2277
免疫記憶されるみたいだから、ひょっとしたらADEも引き継がれてしまうのかなぁ。+4
-0
-
2351. 匿名 2021/09/09(木) 22:25:42
>>2322
コメの鸚鵡返しは頭の悪い証拠だから今後はやめた方がいいよ+6
-1
-
2352. 匿名 2021/09/09(木) 22:25:42
>>1816
釣りかもしれんが子どもの意志を尊重してあげて+4
-0
-
2353. 匿名 2021/09/09(木) 22:25:44
>>2023
病気はコロナだけじゃないならワクチン接種のバイトもできないはずなのにねー笑+5
-0
-
2354. 匿名 2021/09/09(木) 22:25:48
>>2333
傍観してる
アホくさいけどいい時間潰しになる+5
-0
-
2355. 匿名 2021/09/09(木) 22:25:50
>>2251
私も未接種だけどだんだん変なテンションの人が増えてきたね
悩むくらいなら打たない方がいいと思うけどデマを貼り付けるのは間違ってる
もう寝るわ+10
-0
-
2356. 匿名 2021/09/09(木) 22:25:53
>>2108
こっわ🥺+2
-1
-
2357. 匿名 2021/09/09(木) 22:26:11
>>2274
ワクチン関連の本3冊読みました
合ってますよ+7
-3
-
2358. 匿名 2021/09/09(木) 22:26:13
>>2285
ホウライエソは…?+0
-4
-
2359. 匿名 2021/09/09(木) 22:26:18
>>1176
コロナ初期に武漢で人がバタバタと倒れてるという動画をネットで見たけど半信半疑だった
だけど今になって日本でも同じことが起きてる…?+4
-1
-
2360. 匿名 2021/09/09(木) 22:26:18
>>2253
わかる!
おのののののののか
とかに扇動されて大事な子供を台無しにして欲しくないよ。
そもそもワクチン打った同士から産まれた子供が無事に育つかどうかすら分からないのに…命をかけた人体実験する親の気持ちが1ミリも分からない。
日本人で若い人なんて特に罹らないし、重症化もしないし、死なないのに。メディアに騙され過ぎでしょ+101
-5
-
2361. 匿名 2021/09/09(木) 22:26:22
>>420
旦那が催促してきてうざい
私の親の事まで言ってくる。本人が打ちたくないって言ってるんだから尊重してほしい+76
-1
-
2362. 匿名 2021/09/09(木) 22:26:22
>>2302
じゃ、ぜひ5chへ+2
-0
-
2363. 匿名 2021/09/09(木) 22:26:23
>>1935
私の友達は打ってたけど、あなたのことだから、何とも言えないな+2
-0
-
2364. 匿名 2021/09/09(木) 22:26:24
>>2214
アナウンサー日本語不自由なんじゃない?![尾身氏、ワクチン3回目検討提案 宣言解除後の緩和に慎重求める]()
+15
-0
-
2365. 匿名 2021/09/09(木) 22:26:28
>>2255
ビルゲイツは別にこのトピにいるガルちゃん民は求めてないと思う。しらんけど。+4
-2
-
2366. 匿名 2021/09/09(木) 22:26:38
>>1967
人間を奴隷管理するため。
体内に記憶媒体と電気誘導体を体内にいれたら
人間がスマートフォン端末のようになるの。
貴方の今いる場所のデータを吸い上げられたり、
貴方の記憶を書き換えられたりもする。
もう一つは人口削減のため。
酸化グラフェンは熱を発し血液を凝固させ血栓を生じさせたりするわ。
そうなると心筋梗塞や脳梗塞になる。
+14
-1
-
2367. 匿名 2021/09/09(木) 22:26:38
ワクチンを打ってコロナにならないと
思ってる人が多すぎる。
ならないんぢゃなくて重症化しない
ため。って事わ症状が軽くなる。
ってことわ無症状の人だらけで知らない
間に人に移すって事ですよね?
だからワクチン始まってから
東京とか全国のコロナの感染者が
増えたんだと思っています。
私わ打ちません。+3
-3
-
2368. 匿名 2021/09/09(木) 22:26:40
>>2222
私は打たない派だけど、むしろツイッターは反ワクチンの溜まり場な気が…w+11
-0
-
2369. 匿名 2021/09/09(木) 22:26:41
>>2310
自分が上手くいってないからって周りを巻き込むのやめな+6
-0
-
2370. 匿名 2021/09/09(木) 22:26:50
>>315
ファイザーのCEOが自分で答えてるよ、Twitterにもその番組の動画上がってる。
「私は健康なので打ちません」と言ってるよ。+10
-4
-
2371. 匿名 2021/09/09(木) 22:26:55
尾身がインスタ始めた=ワクチン若者ターゲットにされてるね。
ただ、爺だからわからないだろうけど
今インスタて、じじイババあばかりですよ。
若者はアナタのアカウント見ません。+10
-0
-
2372. 匿名 2021/09/09(木) 22:27:05
>>2295
インフルワクチンも自然免疫を後退させるって前から言われてたから、打ったことないわ。
ただ年寄りはインフルワクチン打った方がいいと医者から聞いてる。
これコロナと同じじゃないかな+5
-0
-
2373. 匿名 2021/09/09(木) 22:27:05
>>2264
自己紹介乙+5
-0
-
2374. 匿名 2021/09/09(木) 22:27:14
>>2012
ビルゲイツそこ今チカラ入れてるとこ
もうちょっと待って+0
-0
-
2375. 匿名 2021/09/09(木) 22:27:14
>>2308
やだやだ見るー!+0
-0
-
2376. 匿名 2021/09/09(木) 22:27:16
>>2357
本は正しくないかもよ?+0
-1
-
2377. 匿名 2021/09/09(木) 22:27:16
>>2017
皆コロナストレスたまってるのさ 事件も多いしね+7
-1
-
2378. 匿名 2021/09/09(木) 22:27:17
>>2286
酸化グラフェンはmRNAワクチンの特許。+4
-0
-
2379. 匿名 2021/09/09(木) 22:27:24
>>2322![尾身氏、ワクチン3回目検討提案 宣言解除後の緩和に慎重求める]()
+2
-1
-
2380. 匿名 2021/09/09(木) 22:27:24
打つリスクと打たないリスクを天秤にかけたら後者のほうがはるかに大きいことは自明なわけで、そんな簡単な判断もできない人は勉強も仕事も恋愛も結婚もうまくいかないんだろうな、と思う+6
-5
-
2381. 匿名 2021/09/09(木) 22:27:24
>>2338
セクシーもビニール袋有料化にしても意味はないっていってる
あくまで人の意識が変わるだけ
ビニール袋ってめちゃくちゃ薄いし、そもそもガソリンの副産物で作ってるだけだから+3
-0
-
2382. 匿名 2021/09/09(木) 22:27:35
>>2243
自己免疫力最高なのはいいけど
それを捻じ曲げて捉える人がいるからね。
自己免疫力高めれば絶対病気に罹らないとか
この商品を利用すれば自己免疫力があがりますよ~。とか。+4
-0
-
2383. 匿名 2021/09/09(木) 22:27:39
>>2017
反ワクチン派の方が変な人多いと思う。
打たないなら黙ってそうしたらいいのに否定批判が凄いし、打つ人はバカだの毒珍だの言葉も強い。何がそんなに感情激しくさせるんだろう。+15
-36
-
2384. 匿名 2021/09/09(木) 22:28:01
>>2292
茶番って言いますか
もう冷静になれる時期でしょう?
一年以上こんな具合で
それでもってワクチン始まってからのほうがひどい
後悔してる人も多い印象ですよ
+13
-3
-
2385. 匿名 2021/09/09(木) 22:28:03
>>2347
やばい人ばっかやな+2
-0
-
2386. 匿名 2021/09/09(木) 22:28:09
>>2367
言いたい事わかるけど
「わ」の癖!
お前はayu世代か!+7
-0
-
2387. 匿名 2021/09/09(木) 22:28:10
>>1128
どうせ3回目打たないなら何で今打つんだろうね。どうせ半年で抗体消えるのに
+18
-0
-
2388. 匿名 2021/09/09(木) 22:28:25
>>2216
駆虫薬として飲んでるだけ
+3
-1
-
2389. 匿名 2021/09/09(木) 22:28:28
>>1960
基本的に生活保護と社会保障費を奪い合う高齢者を減らそうとしている。+7
-0
-
2390. 匿名 2021/09/09(木) 22:28:28
いいけどまず、若い人が2回目打ち終わってからにしてね?まだ予約できてない人もいるから、、、+0
-1
-
2391. 匿名 2021/09/09(木) 22:28:29
>>2357
ありがとうございます
友達にも教えます
因みに、ワクチンに混ぜられてる毒ってなんですか?
色々言われてますが、全部本当ですか?+0
-2
-
2392. 匿名 2021/09/09(木) 22:28:41
>>2357
ワクチン関連の本って何⁇誰がどこから出してるの?+0
-1
-
2393. 匿名 2021/09/09(木) 22:28:42
>>2367
わ
とか
ぢゃ
とか辞めろ+4
-0
-
2394. 匿名 2021/09/09(木) 22:28:47
>>1614
ワクチンと因果関係あると思うよ。
姑と旦那 実の母にワクチンいつ打つのか言われているけど今のところ止めておきます。+62
-4
-
2395. 匿名 2021/09/09(木) 22:28:47
>>1896
悲しいかな日本人は人を信じて疑わないとこあるし、テレビにも簡単に洗脳されたりするのかな+11
-0
-
2396. 匿名 2021/09/09(木) 22:28:49
>>1188
思わないでしょ。みんなが打ってるから打たなきゃ。それぐらいしか考えてないよ+11
-32
-
2397. 匿名 2021/09/09(木) 22:28:50
>>2370
去年のヤフーニュースにあったね。
やっぱまだ打って無いのかな。
変異しているし現行ワクチンが意味なくなるのはファイザーはよく知ってそうだけどね。+8
-1
-
2398. 匿名 2021/09/09(木) 22:28:55
>>2229
奴らが打ったのはワクチンという名の生理食塩水だもんね。笑笑+7
-0
-
2399. 匿名 2021/09/09(木) 22:28:58
>>2274
>ワクチンの効果は嘘
>特にデルタ株に対してはデータが無い
>感染予防効果も重症予防効果もない
あるorない、0or100というほど極端なはなしじゃない
「ワクチンの効果は嘘 」というより「はじめに期待された効果より遥かに低く、場合によっては逆作用する中長期的リスクも考えられ始めた」とか+14
-1
-
2400. 匿名 2021/09/09(木) 22:29:00
>>2347
好きw+1
-1
-
2401. 匿名 2021/09/09(木) 22:29:05
>>2233
そこでワクチン登場ってわけね+7
-0
-
2402. 匿名 2021/09/09(木) 22:29:06
>>1837
つまんないよ+5
-0
-
2403. 匿名 2021/09/09(木) 22:29:14
>>1589
あなたは冷静だね。
私もそれで悲しいけど縁を切った人が居る。
でも色々報道や尾身さんのことを見て、これが正解だと信じてる。ワクチン漬けは無理だ。+70
-1
-
2404. 匿名 2021/09/09(木) 22:29:19
>>2378
それは無いわw+1
-1
-
2405. 匿名 2021/09/09(木) 22:29:20
>>2017
ストレス溜まると攻撃力したくなるんだって。ワクチン打ってないからストレスじゃない?+4
-11
-
2406. 匿名 2021/09/09(木) 22:29:37
>>2391
ホウライエソは嘘+3
-0
-
2407. 匿名 2021/09/09(木) 22:29:42
>>1646
わたしも家族に打ってないと言ったら、いつも携帯ばかり信じて!昔からそうだった!と言われた
去年マスク無くなる前に私がガルちゃんみてマスク確保してたときはありがたがってたの、忘れたかな??+53
-3
-
2408. 匿名 2021/09/09(木) 22:29:47
>>2025
はぁ…+1
-0
-
2409. 匿名 2021/09/09(木) 22:29:53
>>1140
ノババックスいつ打てるんだろ+10
-1
-
2410. 匿名 2021/09/09(木) 22:29:58
>>2381
それ環境汚染の話だと思うけど+1
-1
-
2411. 匿名 2021/09/09(木) 22:30:00
>>2360
後期の妊婦さんで打ってから流産したって人(確かツイッターで見た)はなぜか流産はよくあること、でスルーで、コロナにかかってから初期流産した人は騒がれてて疑問を感じたわ…+59
-1
-
2412. 匿名 2021/09/09(木) 22:30:11
>>2366
信じるか信じないかは?+3
-2
-
2413. 匿名 2021/09/09(木) 22:30:13
>>2395
ネットのデマを信じてる人たちは?w
+0
-1
-
2414. 匿名 2021/09/09(木) 22:30:18
>>166
みんな堂々としてようよ!
打てワクに負けてはいけない。こっちは反ワクでもないんだし、基礎疾患あってもなくても理由なくても「打ちたくないんで」って堂々としてよう。
あれこれ言われても「私は打たないんで」でぶったぎろう。
退職に追い込まれたら訴えたら勝てるんだから。+151
-5
-
2415. 匿名 2021/09/09(木) 22:30:19
>>2383
やっぱり打ってないことが、多少怖いんだと思う。+8
-19
-
2416. 匿名 2021/09/09(木) 22:30:22
>>2169
未接種者の中には接種してから2週間経ってない人も含まれるって聞いたけど、どうなんだろ+1
-0
-
2417. 匿名 2021/09/09(木) 22:30:28
>>2333
ワクチン打ってないから楽しんで見てる。+3
-0
-
2418. 匿名 2021/09/09(木) 22:30:30
>>105
でも普通の内科に来られても怖すぎるよ+3
-22
-
2419. 匿名 2021/09/09(木) 22:30:36
>>38
もうなってる人いるでしょ
もはや洗脳+21
-1
-
2420. 匿名 2021/09/09(木) 22:30:36
>>2359
どこで(゜Д゜≡゜Д゜)?+1
-0
-
2421. 匿名 2021/09/09(木) 22:30:52
毎日濃い緑茶と、のどがえらえらしたら塩うがい。3年前を最後に、そこへんの風邪すらひかんよ。+3
-1
-
2422. 匿名 2021/09/09(木) 22:30:56
>>2277
そうですか
そう思うなら打てばいいと思いますよ
自由ですから
私は中身を知らないので遠慮しておきます+5
-1
-
2423. 匿名 2021/09/09(木) 22:31:05
>>2409
わたしも待ちー+12
-0
-
2424. 匿名 2021/09/09(木) 22:31:09
>>337
10代の子アナフィラキシーになった子多数いる
子供はコロナで重症化ほとんどしないのに重篤な症状出てるし…![尾身氏、ワクチン3回目検討提案 宣言解除後の緩和に慎重求める]()
+79
-1
-
2425. 匿名 2021/09/09(木) 22:31:14
>>2264
ア○ペはいい過ぎだけど、そうだよね
実親も姑も既に2回接種済みだし、友達もママ友も夫も夫の友達も打ったorこれから打つ人ばかりだよ。
少し前は迷ってる人も多かったけど、今はそんな人いないよ
私の住んでる市でも6割は1回目接種ずみだよ+2
-8
-
2426. 匿名 2021/09/09(木) 22:31:17
>>2405
相当頭悪いねこの人+7
-1
-
2427. 匿名 2021/09/09(木) 22:31:17
>>2367
じゃあ重症化する人が増え続けて、医療崩壊待ったなしで自宅で死にまくりですね。+2
-0
-
2428. 匿名 2021/09/09(木) 22:31:20
>>2074
SDGsの一環で、各国削減目標が与えられてしまってるとか?+7
-0
-
2429. 匿名 2021/09/09(木) 22:31:27
>>2379
ほとんど打ってるね+3
-0
-
2430. 匿名 2021/09/09(木) 22:31:29
あのさ高市早苗のすごい人気を一切ない事にして石破茂や河野太郎を人気者扱いにしてる報道をしている時点でTVが真実なんかこれっぽっちも伝えていないといい加減に気付こうよ
コロナもおんなじなんだ
20代や30代なんか何にも怖くないよ
ワクチンで死んだ人の方が多いから!![尾身氏、ワクチン3回目検討提案 宣言解除後の緩和に慎重求める]()
+26
-1
-
2431. 匿名 2021/09/09(木) 22:31:30
コロナは、ただの風邪では無いと思う。
コロナワクチンも、ただのワクチンでは無いとおもう。
どっちも恐いわ。+16
-0
-
2432. 匿名 2021/09/09(木) 22:31:35
>>1971
酸化グラフェンは解毒できる。
寄生虫も駆除できる。
でもmRNAは体内から取り除けないと思う。+7
-0
-
2433. 匿名 2021/09/09(木) 22:31:37
>>509
打ったから日常生活に戻れる!ってばら撒きまくってるんじゃないの+15
-2
-
2434. 匿名 2021/09/09(木) 22:31:39
>>2405
打ってない人がどんどん減ってるから孤立感が強まってる。+1
-5
-
2435. 匿名 2021/09/09(木) 22:31:45
>>1148
そう、世間との乖離はひどい。
日本中のワクチン打たない人が全てここに集中しているんではないか?くらい。
若い人の方が早くに打って、お前は一番に打っとけや!というメタボおっさん連中が慌てて今打ってます。
ガル民は年齢層が高い?+7
-2
-
2436. 匿名 2021/09/09(木) 22:31:52
まだ1回も打ててないのに
3回目とか
+0
-0
-
2437. 匿名 2021/09/09(木) 22:31:53
>>2383
打って無い人は打ってる人は頭おかしいヒステリックな人が多いと思ってる。
もう後戻りできないし、mRNAが起こす悲惨な未来におびえてると。
お互いさま+14
-6
-
2438. 匿名 2021/09/09(木) 22:31:58
>>2370
ファイザーCEOは2回ワクチン接種済です。
彼は「私はまだ打つ順番じゃない。59歳で健康、私より先に打つ人がいる」と言いました。
インタビュー当時は基礎疾患持ちや高齢者、医療従事者の優先接種時期です。米国ではワクチンの順番が厳格に決められている中、特権者が順番を抜かしてワクチンを打つことが問題視されていた時期でもありました。
反ワクチンの方々は「私は健康なのでまだ打たない」の部分だけを切り取り、拡散しました。
+12
-12
-
2439. 匿名 2021/09/09(木) 22:32:05
>>2383
それ真逆かと思ってたけど+20
-4
-
2440. 匿名 2021/09/09(木) 22:32:05
>>337
私もアレルゲンは口にしてないのに、食事終わって30分後ぐらいに体が真っ赤になってものすごい眩暈と胃の痛みに同時襲われて、呼吸困難起こしたよ。
アレルギー体質だからって断ったのに、会場には医者も看護師もいるし薬もあるからもぢアナフィラキシーになって大丈夫!って言われてびっくりしたわ。
何が大丈夫なんだよ…+63
-1
-
2441. 匿名 2021/09/09(木) 22:32:07
>>2383
どうもね、ガルちゃんの世界だけなんだよねここまで反ワクチンの人って。職場、近所、学校、園、リア友、SNSのフォロワー、圧倒的に打ってるからすごい差+21
-18
-
2442. 匿名 2021/09/09(木) 22:32:10
>>2432
松葉茶があるじゃんw+0
-0
-
2443. 匿名 2021/09/09(木) 22:32:15
>>2383
マイノリティが怖いんだよ。
まだ何かしらの理由で打てないんだったら堂々とできるけど
最近周囲が打ってるから不安なのよ。
自分は正しい!としておいたほうが心の安定が保てるじゃん。+8
-14
-
2444. 匿名 2021/09/09(木) 22:32:26
>>2351
どれに言ってる?+0
-0
-
2445. 匿名 2021/09/09(木) 22:32:28
>>1914
ほとんどの人が、コンビニの弁当の裏表示も見ずに食べてるでしょ、それと一緒。見たら怖くて食べれんけどw+7
-0
-
2446. 匿名 2021/09/09(木) 22:32:31
>>189
イスラエルでワクチン前と後で感染者数が同じ日をピックアップして重症化率を調べてみたよ
イスラエル 2021年 1月 ワクチン接種前
感染者数 9000人 (感染率0.1%)
重症者数 250人 (重症化率2.5%)
イスラエル 2021年 9月 ワクチン接種後(3回目も含む)
感染者 9000人(感染率0.1%)
重症者数 210人(重症化率2%)
イスラエル ワクチン接種終了時の数字予想
感染者が9000人なら→500人(95%発症予防)
重症者が250人なら→25人(重症化予防90%)
ワクチンが本当に発症予防や重症化予防効果があるならこんな数字にならないんじゃないかな?+85
-1
-
2447. 匿名 2021/09/09(木) 22:32:31
>>1646
私だったら息子や娘が若かったら、逆に慎重に考えるのよ、て言うなぁ。まだ子供2歳だけど。
何で平気で子供に打ちなさいって言えるんだろ。
そしてテレビは正解ネットは不正解に思う人や、仕向ける人。
自由に意見が話せるし、取捨選択出来る唯一の場だと思うの。テレビは一方通行だし。+55
-1
-
2448. 匿名 2021/09/09(木) 22:32:37
>>2435
あなたは日本語が酷い+1
-0
-
2449. 匿名 2021/09/09(木) 22:32:45
>>2409
今のところ3回目とインフルワクチンの混合での使用だね。2回接種済の人が打つんだと思う!一回目から打つ日はその後かな?+5
-3
-
2450. 匿名 2021/09/09(木) 22:32:52
>>2399
ワクチンの危険性を知ってる人だけ返信してください
洗脳されてる人の意見は求めてないです+3
-4
-
2451. 匿名 2021/09/09(木) 22:32:52
>>2409
ノババックスの方が良いんですか?+8
-0
-
2452. 匿名 2021/09/09(木) 22:33:01
>>2442
お、おう。+0
-0
-
2453. 匿名 2021/09/09(木) 22:33:03
>>2314
5chなんてどの板でもワクチンリスクのニュースの度に煽り立ててるのに
がるちゃんでいう大多数の慎重派も面白がって反ワク的に振る舞って打った人煽ってるのが日常だよ
安倍菅隷属系の人種が固まってるニュー速+くらいじゃないの?打てワクなんかが主流なの+1
-1
-
2454. 匿名 2021/09/09(木) 22:33:08
メッセンジャー発明した人がやめとけって言ってる動画があったじゃん
悪いけど私はそっちを信じるわ+11
-0
-
2455. 匿名 2021/09/09(木) 22:33:10
ワクチンパスポートやっても、別に困らなくない?
打った人がばらまくのが不安だけど、でも、ワクチン打たないけど、感染予防はちゃんとしてるし、出かけたりなんてしないし。差別とか気にしない。+10
-2
-
2456. 匿名 2021/09/09(木) 22:33:18
感染者が全くいない地方の田舎ならワクチン打たなくても良いよね
+18
-0
-
2457. 匿名 2021/09/09(木) 22:33:21
>>2441
流石にこの報道見た時は騙された感あったけど。
無いの?
凄いね色んな意味で。+7
-3
-
2458. 匿名 2021/09/09(木) 22:33:21
>>1934
すっごく馬鹿な質問かもしれませんが。。
今半導体不足ですよね
それで私が働く工場止まってます
もしかして、ワクチンに使ってるから半導体不足?
それとはまた違う半導体?+13
-1
-
2459. 匿名 2021/09/09(木) 22:33:24
>>2443
なるほどなー+1
-1
-
2460. 匿名 2021/09/09(木) 22:33:31
>>2383
だよね、ほとんどの人打ってるし副反応なんてほぼないし+2
-18
-
2461. 匿名 2021/09/09(木) 22:33:32
ワクチン打った人たちの慰め合い場と化してて草
1回目、2回目ぐらいなら大丈夫じゃない?(鼻ホジ)
知らんけど(鼻くそピーン)+1
-5
-
2462. 匿名 2021/09/09(木) 22:33:33
>>2214
何か、国語の問題みたいになってる…
『表現が間違ってる箇所はどこですか?』+5
-0
-
2463. 匿名 2021/09/09(木) 22:33:37
>>2430
選挙とコロナは一緒ではない。
知り合いの子どもさんが10歳で重症化してるから私はなんとも言えん。+0
-10
-
2464. 匿名 2021/09/09(木) 22:33:39
>>2255
事実は小説より奇なり…
+2
-0
-
2465. 匿名 2021/09/09(木) 22:33:40
ファイザーワクチン 来月中にすべて輸入完了 予定を前倒し
![ファイザーワクチン 来月中にすべて輸入完了 予定を前倒し | 新型コロナ ワクチン(日本国内) | NHKニュース]() ファイザーワクチン 来月中にすべて輸入完了 予定を前倒し | 新型コロナ ワクチン(日本国内) | NHKニュースwww3.nhk.or.jp
ファイザーワクチン 来月中にすべて輸入完了 予定を前倒し | 新型コロナ ワクチン(日本国内) | NHKニュースwww3.nhk.or.jp【NHK】新型コロナウイルスのファイザーのワクチンについて、河野規制改革担当大臣は記者団に対し、来月から12月にかけて予定されてい…
+0
-0
-
2466. 匿名 2021/09/09(木) 22:33:43
>>1865
すでに短期間で4回打った方が数名…
よくわからんけど体調崩したとかは無いみたいよ
+5
-0
-
2467. 匿名 2021/09/09(木) 22:33:44
>>2182
黄熱病はずっと抗体つくよ。+0
-2
-
2468. 匿名 2021/09/09(木) 22:33:44
>>1392
海外でマスクしないでスポーツ観戦して6000人くらい感染してなかった?わりと最近。+1
-0
-
2469. 匿名 2021/09/09(木) 22:33:47
ワクチン接種して丸剥げになった若い女性いましたよね!?
あの方の事はテレビで特集しないのかな?
もろ、ワクチンの仕業ですよね?+19
-0
-
2470. 匿名 2021/09/09(木) 22:33:53
>>750![尾身氏、ワクチン3回目検討提案 宣言解除後の緩和に慎重求める]()
+1
-14
-
2471. 匿名 2021/09/09(木) 22:33:55
>>2401
コロナで殺してワクチンで殺して…
本当に現在進行形で起きてること?!
+7
-0
-
2472. 匿名 2021/09/09(木) 22:33:59
>>2401
食べ物にも気をつけた方がいいよ。+2
-0
-
2473. 匿名 2021/09/09(木) 22:34:11
>>1517
早速調べました。勉強になりました!
教えて下さってありがとう。
国産待ちの周りの知人にシェアします。+35
-1
-
2474. 匿名 2021/09/09(木) 22:34:12
>>2164
ワク打った人と一緒にいると具合が悪くなるのよね。
何がメリット???+14
-11
-
2475. 匿名 2021/09/09(木) 22:34:13
>>2418
コロナが怖いウイルスって思い込まされているんだよ。いい加減気付け。ニュースてま煽って、違うスタジオで
ドラマのキスシーン撮るか?
バラエティーでアホ笑いして、地方ロケ行くか?
歌番組するか?
国民は屋外でも😷😷😷
+78
-5
-
2476. 匿名 2021/09/09(木) 22:34:14
>>2383
いや、ワクチン打った人も中々だよ。
「棲み分け必要!」とか「打ってない人との区別化を作れ!パスポートはよ!」て、結局ワクチン打ってない人を差別化するからね。
何がそんなに…
←共通して言えるのが、私達は実験中で正解がわからないからこそ過剰に感情を剥き出しにする人が居るんだろうね。
コロナ終わっても仲良くしたいなと思う。
だって、何十年後かの人間から見たら
どちらもバカ過ぎwwなんだろうから。+19
-2
-
2477. 匿名 2021/09/09(木) 22:34:21
会社でワクチン打ってない人、私は胃が健康だから打たなくても平気だの言ってるけど意味不明+0
-0
-
2478. 匿名 2021/09/09(木) 22:34:24
>>2436
誰に3回目って言ってるんだろう高齢者?一回目予約できてるのか?若い人は
うちの市は12-29の予約が8月後半に始まって予約はできてると思うけど接種は10月とかだと思うぞ?
9月は40代の2回目が終わるのと、30代の一回目が終わる日程なんだと思う。+0
-0
-
2479. 匿名 2021/09/09(木) 22:34:29
>>2446
北半球の夏でこれって、また1月が来たら前回より数倍やばいことになるだろうね。
ワクチンが意味ないことがまた証明される。+46
-0
-
2480. 匿名 2021/09/09(木) 22:34:37
>>2410
疫病の次は環境問題なんだよね+0
-1
-
2481. 匿名 2021/09/09(木) 22:34:43
>>2442
ドクダミ茶も捨てたものではない
ネーミング的にはこっちが勝ち(笑)+2
-0
-
2482. 匿名 2021/09/09(木) 22:35:00
>>815
本当にそう思う。
コロナなんかよりこっちの方が怖いわ😱+18
-0
-
2483. 匿名 2021/09/09(木) 22:35:01
>>2456
それはいいと思う。場所によるかと+1
-0
-
2484. 匿名 2021/09/09(木) 22:35:02
>>1000
あらあら本音ポロリ打てワク、ワクチン推進強要派w+46
-0
-
2485. 匿名 2021/09/09(木) 22:35:11
>>2327
>少し出かけたいのが本音。
打っても感染するし無症状スプレッダーになるのがオチなのでやめてください+3
-2
-
2486. 匿名 2021/09/09(木) 22:35:14
>>1
総理の会見で言ったのかな?
結構これまでの政策が分かりやすくていい会見だった
ほんとに大変なことを短期間で色々やってくれて菅総理でよかったなと初めて思ったよ+4
-3
-
2487. 匿名 2021/09/09(木) 22:35:18
3回目~になるとまたネット使えない年寄り達が大変だから予約方法どうにか変えた方がいいかもね
いつまでワクチン打つのかなぁ。特効薬早く出て来ないかなぁ
半年毎だとキッツイわ+2
-0
-
2488. 匿名 2021/09/09(木) 22:35:24
>>2242
本当こういう人たちってTwitter好きだねw
正式に公開されてるものを信じないのは別に自由だけどなぜ正式なものではなくよくわからない怪しいソースは信じるのか。+3
-8
-
2489. 匿名 2021/09/09(木) 22:35:34
>>809
本当かはわからないが、Twitterでワクチン打つ看護師さんが、医療従事者用のロットは別に確保してあると言ってる人がいた。
つまり、ロットによって濃度が異なり、mRNAの量が多い物に当たってしまった小柄な女性なんかは副反応がひどく、少ないものに当たった人は副反応が少ないのでは?ワクチンルーレット?なんて話が一部で出てる。信憑性はなぞですが。+31
-0
-
2490. 匿名 2021/09/09(木) 22:35:48
うちの会社でワクチン打った人は、ユーチューバーとかに騙されて変なもの買ってる人ばっか。
詐欺にあいやすい思考なんだろう。+6
-2
-
2491. 匿名 2021/09/09(木) 22:35:49
>>2456
国は接種者対象にこれからどんどん旅行して経済回せ的なこと言ってるよ+5
-0
-
2492. 匿名 2021/09/09(木) 22:35:51
>>2476
当たり前じゃない?打ってない人が近くにいるのは怖いもん。同じ感染でも打ってない人が感染したら重症化するんだもん。打ってる同士ならブレイクスルー同士でいいかもしれないけど+1
-13
-
2493. 匿名 2021/09/09(木) 22:35:53
>>2222
反ワクチンのTwitterアカウント(フォロワー1000人以上)がガルちゃんに書き込んでくださいと誘導してたよ。
TwitterやYouTube、インスタはワクチンのデマ情報に注意喚起してたり垢BANするけど、ガルちゃんは無法地帯。反ワクチンの巣窟になってる+11
-8
-
2494. 匿名 2021/09/09(木) 22:35:54
>>2432
役目が終わったら消えるのよ。それが欠点だけど逆に利用したんだって。+2
-4
-
2495. 匿名 2021/09/09(木) 22:35:58
>>2431
そ
未知すぎる
毎週のよう情勢変わる
だからこそこんなにすぐにワクチンを打てる人の気が本当に知れない
でも否定はしない
だから打たない私のこともほっとけ+9
-0
-
2496. 匿名 2021/09/09(木) 22:36:03
>>2384
コロナが蔓延してることを冷静に受け止めて、感染予防しながら毎日満員電車に乗って仕事してますけど
福祉の仕事してるので、私が子ども達に感染させたら本人達や保護者に申し訳ないのでコロナを軽視するわけにはいきません+6
-0
-
2497. 匿名 2021/09/09(木) 22:36:05
>>2455
日本でこのパスはかなりグダグダなって形骸化するか無くなりそう。
追加接種していかないと取り上げられるだろうしね。そもそも抗体付かない人も。
尾身インスタで何千件と反対や抗体切れどうすんの?て来てんのに無視だった。今は返信してんのかな?+4
-0
-
2498. 匿名 2021/09/09(木) 22:36:06
>>245
自殺行為だよ!
絶対やめとけって言いたい。+5
-3
-
2499. 匿名 2021/09/09(木) 22:36:10
とりあえず全世界の人に行き渡ってからにしろ
+0
-0
-
2500. 匿名 2021/09/09(木) 22:36:12
>>2476
ほとんどの人打ってるから仲良くできるよ+1
-3
コメントを投稿する
トピック投稿後31日を過ぎると、コメント投稿ができなくなります。削除すべき不適切なコメントとして通報しますか?
いいえ
通報する